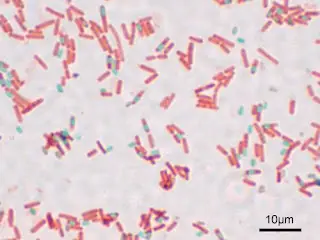
Solamente ciencia, y algo mas (1)

CERROTARINGA
Usuario (Paraguay)
![Terminando el 2009- Megapost! [No te lo pierdas]](https://storage.posteamelo.com/assets-adonis/assets/2009/11/02/15g2hhu-QM9i6pqhMQg.gif)
Hola gente de taringa, bueno me decidí hacer este post para no sólo recordar los hechos más resaltantes del 2009, sino también para ver desde el avance tecnológico hasta inclusive lo que pasó en taringa seguramente faltará algunos pero estos son los que mejor estubo a mi alcance si por ahi faltase algo solo agreguen en los comentarios y yo los voy a actualizar. INTRODUCCION Terminando este nuevo año, el 2009 a sido un año maravilloso quizas muchos acontecimientos importantes, nuevas herramientas de tecnologías-avance informáticos-autos-programas-juegos, y películas que impresionaron a mucha gente, nuevos descubrimientos, algunos misterios y mucho más. Este año ha sido vertiginoso. Los titulares de todos los diarios del mundo y portales de Internet, nos mostraron noticias que, en muchos casos, tardamos en asimilar. También fue el año en el que las redes sociales, el Twitter y el Skype, convirtieron a muchos ciudadanos en intérpretes de la realidad y periodistas, en muchos casos. La tecnología estuvo mas presente que nunca y al alcance de nuestras manos. Fue el año de la gripe AH1N1, y de la fiebre de estadios: este año asistimos a eventos musicales increíbles, pero reales. Acumulamos títulos mundiales y escándalos mediáticos. Para comenzar › El Año del buey, según el horóscopo chino. › El Año Internacional de la Astronomía, según la ONU. › El Año Internacional de la Reconciliación, según la ONU. › El Año Internacional de las Fibras Naturales, según la ONU. › El Año Internacional del Aprendizaje sobre los Derechos Humanos, según la ONU. › El Año Internacional del Gorila, según la ONU. › El Año de Nikolái Gógol, según la Unesco. › El Año de José María Morelos y Pavón, Siervo de la Nación, según el Gobierno del Estado de México. › El Año de la Unión Nacional Frente a la Crisis Externa, en el Perú. › El Año de la juventud, en Rusia. › El Año Europeo de la Innovación y la Creatividad. › El Año de Darwin, según la International Union of Biological Sciences (IUBS). Ciencia y tecnología 3 de febrero: se anuncia el descubrimiento de COROT-7b, el primer planeta extrasolar rocoso. 16 de marzo: el transbordador espacial Discovery es lanzado con éxito desde el centro espacial John F. Kennedy de Florida, portando paneles solares para la Estación Espacial Internacional. 5 de abril: Corea del Norte lanza el Kwangmyongsong-2, descrito como un satélite de comunicaciones experimental, bajo una fuerte controversia internacional.[523] 30 de junio: es lanzada la versión 3.5 del navegador Firefox, de la Fundación Mozilla. Entre sus nuevas características está la posibilidad de elegir versiones en idioma español de Chile y de México (si bien en fase beta), además de las previamente existentes de Argentina y España.[524] Septiembre: es descubierta la Rata lanuda de Bosavi en Papúa Nueva Guinea. 22 de octubre: lanzamiento mundial[525] del sistema operativo Windows 7 de Microsoft,[526] para reemplazar a Windows Vista.[527] 13 de noviembre: la NASA confirma la existencia de "significativas cantidades de agua" en la Luna.[528] CON UN POCO MAS DE INFORMACIÓN: AGUA EN LA LUNA La Agencia Espacial de Estados Unidos (NASA) anunció el hallazgo de "cantidades importantes" de agua en la Luna, lo que abre un nuevo capítulo en la exploración del satélite terrestre. La agencia había hecho impactar un cohete y una sonda en un cráter de gran tamaño en el polo sur de la Luna esperando detectar hielo en su superficie. Los científicos que han estado estudiando los datos ahora aseguran que los instrumentos diseñados para captar información durante el impacto encontraron importantes cantidades de vapor de agua en la nube de escombros. Un investigador describió el hallazgo como el equivalente a "una docena de recipientes de dos galones" de agua. EL LOGO DE GOOGLE El lanzamiento de Windows 7 Bueno este es la version de sistema operativo más nueva de windows hasta el momento. Windows 7 es la versión más reciente de Microsoft Windows, un sistema operativo producido por Microsoft para uso en PCs, incluyendo equipos de escritorio en hogares y oficinas, equipos portátiles, "tablet PC", "netbooks" y equipos "media center". El desarrollo de Windows 7 se completó el 22 de julio de 2009, siendo entonces confirmada su fecha de venta oficial para el 22 de octubre de 2009 junto a su equivalente para servidores Windows Server 2008 R2. SITIO OFICIAL Graba tus videos en con la Zx1 link: http://www.videos-star.com/watch.php?video=CYnSGTUU4P0 Cine Estrenos Abril 10 de abril Dragonball Evolution de James Wong. 17 de abril 17 otra vez de Burr Steers Mayo 1 de mayo X-Men Origins:Wolverine de Gavin Hood. 8 de mayo Star Trek XI de J. J. Abrams. 15 de mayo Ángeles y demonios de Ron Howard. 22 de mayo Terminator Salvation de Joseph McGinty Nichol. Junio 24 de junio Transformers: la venganza de los caídos de Michael Bay. Julio 1 de julio Ice Age 3: Dawn of the Dinosaurs de Carlos Saldanha. 15 de julio Harry Potter y el misterio del príncipe de David Yates. Agosto 21 de agosto Destino final 4 de David R. Ellis. Octubre 28 de octubre This is it de Kenny Ortega. Noviembre 13 de noviembre 2012 de Roland Emmerich 20 de noviembre Luna Nueva de Chris Weitz. Diciembre 4 de diciembre Spanish Movie de Javier Ruiz Caldera. 12 de diciembre One Piece Film Strong World de Echiro Oda 18 de diciembre Avatar de James Cameron. Efemérides * 1 de enero: 50.º aniversario de la Revolución Cubana. * 19 de enero: 200.º aniversario del nacimiento de Edgar Allan Poe. * 3 de febrero: 200.º aniversario del nacimiento de Felix Mendelssohn-Bartholdy. * 12 de febrero: 200.º aniversario del nacimiento de Charles Darwin. * 24 de marzo: 200.º aniversario del nacimiento de Mariano José de Larra. * 14 de abril: 250.º aniversario del fallecimiento de Georg Friedrich Händel. * 18 de mayo: 100.º aniversario del fallecimiento de Isaac Albéniz. * 31 de mayo: 200.º aniversario del fallecimiento de Joseph Haydn. * 24 de junio: 150.º aniversario de la fundación de la Cruz Roja. * 26 de julio-2 de agosto: 100.º aniversario de la Semana Trágica de Barcelona. Para lo malo en el 2009 hubo tambien cosas malas como la famosa gripe H1N1 que veremos a continuacion. Pandemia de gripe A (H1N1) de 2009 La gripe A (H1N1) de 2009 es una pandemia causada por una variante del Influenzavirus A de origen porcino (subtipo H1N1), conocido oficialmente por la Organización Mundial de la Salud como Virus H1N1/09 Pandémico. Esta nueva cepa viral es conocida como gripe porcina (nombre dado inicialmente), gripe norteamericana (propuesto por la Organización Mundial de la Salud Animal) y nueva gripe (propuesto por la Unión Europea),pobres que han sido objeto de diversas controversias. El 30 de abril de 2009 la Organización Mundial de la Salud (OMS) decidió denominarla gripe A (H1N1). Ésta es una descripción del virus en que la letra A designa la familia de los virus de la gripe humana y de la de algunos animales como cerdos y aves y las letras H y N (Hemaglutininas y Neuraminidases) corresponden a las proteínas. El origen de la infección es una variante de la cepa H1N1, con material genético proveniente de una cepa aviaria, dos cepas porcinas y una humana que sufrió una mutación y dio un salto entre especies (o heterocontagio) de los cerdos a los humanos,contagiándose de persona a persona. Según expertos (como el jefe del Departamento de Microbiología del Hospital Mount Sinai de Toronto, el doctor Donald Low), está por confirmarse la relación entre el virus de la gripe porcina H1N1 y el de los casos confirmados en México. El 11 de junio de 2009 la Organización Mundial de la Salud (OMS) la clasificó como de nivel de alerta seis; es decir, pandemia actualmente en curso que involucra la aparición de brotes comunitarios (ocasionados localmente sin la presencia de una persona infectada proveniente de la región del brote inicial). Ese nivel de alerta no define la gravedad de la enfermedad producida por el virus, sino su extensión geográfica. La tasa de letalidad de la enfermedad que inicialmente fue alta, ha pasado a ser baja al iniciar los tratamientos antivirales a los que es sensible, sin embargo la futura evolución del virus es impredecible, como constata la directora general de la OMS Margaret Chan el 4 de mayo, ya que "puede que en un mes este virus desaparezca, puede que se quede como está o puede que se agrave." Síntomas: Los síntomas de este virus nuevo de la influenza H1N1 en las personas son similares a los síntomas de la influenza o gripe estacional. Incluyen fiebre muy alta (38 y 40º), tos seca recurrente, dolor de garganta, moqueo o secreción nasal, dolores en el cuerpo, dolor de cabeza, escalofríos, fatiga, dolor en los ojos, pérdida del apetito, problemas para respirar como falta de aliento. Una cantidad significativa de personas infectadas por este virus también ha informado tener vómito y diarrea. En este momento no se conocen los grupos de personas que corren un alto riesgo de contraer la nueva influenza A (H1N1), pero es posible que sean los mismos que sufren complicaciones por la influenza estacional. Por suerte ya no hay más casos Las muertes de famosos en el 2009 Jett Travolta: el hijo de John Travolta y de Kelly Preston de tan sólo 16 años murió a principios de 2009 por cuestiones de salud ya que el niño padecía autismo. Desgraciadamente no sólo tuvieron que lidiar con eso los actores, sino también con una extorsión que les trataron de hacer. Michael Jackson: ¿qué se puede decir de él que no hayamos dicho ya? su muerte fue impactante no sólo para los fans, sino también para los que desconocíamos casi toda su vida. Si para generaciones la muerte de Elvis Presley y de John Lennon marcaron un hito en la historia, para la nuestra indudablemente será la muerte del rey del pop. Patrick Swayze: una gran pena la pérdida del actor, que luchó valientemente contra el cáncer de páncreas que lo aquejaba desde hace más de un año. Farrah Fawcett: el gran símbolo sexual de los 70’s, esta angelita de Charlie no pudo tampoco en la batalla contra el cáncer y, aunque era esperado, fue doloroso para toda la gente que la rodeaba, quería y admiraba. DJ AM: Adam Goldstein, uno de los dee-jays de las estrellas, tuvo una vida bastante complicada. No sólo por sus problemas de drogas, también por haber sobrevivido a un accidente aéreo bastante grave que, irónicamente, lo hizo aficionarse más a las drogas y eso fue lo que lo llevó trágicamente a la muerte. Natasha Richardson: la esposa de Liam Neeson esquiaba durante una vacación y sufrió una caída, que aparentemente no había tenido mayor consecuencia, pero al paso de las horas empezaron a salir problemas médicos y no sobrevivió. El clan Kennedy perdió a dos miembros relevantes en la comunidad política y social de Estados Unidos, a Eunice y Ted Kennedy, que afortunadamente tuvieron una larga y productiva vida. La cantante folklórica argentina Mercedes Sosa también es de las que se fueron este año, llenando de tristeza a sus fans. Las muestras de cariño por ella fueron impresionantes. Mike Tyson perdió a su pequeña hija Exodus Tyson después de un accidente doméstico y la niña de cuatro años también murió. Los mexicanos Beto El Boticario Jorge Vargas y Pedro Infante Jr. dejaron también su hueco en el mundo de la farándula nacional. Ed McMahon, David Carradine y Billy Mays, representativos de la televisión norteamericana, murieron también. La actriz Brittany Murphy fallecería de un paro cardiaco. Pareciera que las muertes fueron interminables pero tal vez ahora nos tocó presenciar la pérdida de gente muy notoria y conocida en el mundo del espectáculo. Esperamos que el 2010 sea diferente. Lo más buscado en Internet en el 2009 Google, Yahoo y Bing presentaron la lista de las palabras que la gente más buscó en la Red. Michael Jackson, Twitter, Windows 7, Megan Foxx y Lady Gaga son algunos de los términos que los usuarios de Internet en todo el mundo más buscaron durante el 2009, según las mediciones hechas por los principales servicios en Yahoo, Google y Bing de Microsoft. En el caso de Google, la lista le encabeza el desaparecido Rey del Pop seguido de Facebook y New Moon de la saga de cine sobre vampiros. Al interior de Yahoo, Jackson también se ubicó como la búsqueda más hecha, por encima de otras personalidades como la actriz Megan Foxx, Britney Spears y Naruto. Entre tanto en el servicio de búsquedas de Microsoft, Bing, que tiene apenas algunos meses de existencia, también reportó a Michael Jackson como el término más indagado, seguido de Twitter y la gripa AH1N1. En Colombia, según Google, las palabras más indagadas fueron Facebook, Youtube, juegos, videos y Sena, entre otros. Sobre las búsquedas de personalidades, Google señaló que en nuestro país las más preguntadas en su servicio fueron Shakira, Laura Acuña, Juanes, Ana Karina, Silvestre Dangond, Carolina Cruz, Sara Corrales, Jorge Celedón y Fanny Lu, principalmente. Destaca, en el tema económico, la presencia de términos como DMG y pirámides dentro de la lista de los más buscados en Internet en Colombia. Búsquedas favoritas de los niños en el 2009 Como sucede todos los años, al llegar a los últimos días de diciembre nos encontramos con todo tipo de listas, como la de los vídeos más vistos de YouTube, y hoy no es la excepción por lo que vamos a hablar de las búsquedas favoritas de los niños en el 2009. Generalmente las listas de búsquedas nos permiten conocer un poco más sobre los temas de interés en la web durante el ultimo año, pero la división OnlineFamily.Norton de Symantec decidió cambiar un poco y enfocarse en los más pequeños de la casa. Para sorpresa de nadie, en los primeros tres lugares nos encontramos con algunos de los sitios más populares del mundo, como YouTube, Google y Facebook. La sorpresa real la encontramos en los siguientes dos puestos dado que los más buscados fueron sex (sexo) y porn (porno). Por si no lo conocen, OnlineFamily.Norton es un servicio gratuito que Symantec ofrece a los padres para mantenerse informados de la actividad de los niños en Internet, y en este caso se enfocaron en las búsquedas realizadas por ellos. Para hacer esta lista, los analistas estudiaron los hábitos de búsqueda de los menores de 18 años durante todo el año, y para ofrecer más detalles luego fueron divididos por rango de edad y genero. Según lo informado, las tres búsquedas más importantes (YouTube, Google, Facebook) fueron idénticas para niños y niñas. En el cuarto lugar los niños buscaron sexo mientras que las niñas se enfocaron en Taylor Swift. Finalmente en el quinto los niños buscaron porno, mientas que las niñas buscaron sexo. En total Norton indico que 12% de los niños buscaron contenidos para adultos, comparado con solo el 2% de las niñas. Otras búsquedas interesantes incluyen a Michael Jackson, en el puesto 13, y Bing, en el puesto 100. Además, YouTube demuestra su éxito al conseguir no solo el primer puesto, sino también el sexto y el décimo, gracias a ingresos como YouTube.com y You Tube. You tube En el frente musical encabeza el plagio del “fenómeno Fort”, con unas 82 millones de entradas al “I Know You Want Me” de Pitbull (que es, aproximadamente, la cantidad de veces que escucharemos el tema durante enero), seguido por “The Climb” de Miley Cyrus (con 64+). La bendita lista, a continuación: Los videos Más Vistos en YouTube (Global): 1. Susan Boyle - Britain’s Got Talent (120+ millones) 2. David After Dentist (37+ millones) 3. JK Wedding Entrance Dance (33+ millones) 4. New Moon Movie Trailer (31+ millones) 5. Evian Roller Babies (27+ millones) Los videos Musicales Más Vistos en YouTube (Global): 1. Pitbull “I Know You Want Me” (82+ millones) 2. Miley Cyrus “The Climb” (64+ millones) 3. Miley Cyrus “Party in the U.S.A.” (54+ millones) 4. The Lonely Island “I’m On a Boat” (48+ millones) 5. Keri Hilson “Knock You Down” (35+ millones) Los términos de búsqueda que han crecido más rápido en Youtube por mes (Global): Enero: inauguration Febrero: christian bale Marzo: the climb Abril: susan boyle Mayo: pacquiao vs hatton Junio: michael jackson thriller Julio: michael jackson Agosto: usain bolt Septiembre:kanye west Octubre: paranormal activity Noviembre: bad romance Diciembre: tiger woods 1 Graba tus videos en con la Zx1 link: http://www.videos-star.com/watch.php?video=9lp0IWv8QZY 2 Graba tus videos en con la Zx1 link: http://www.videos-star.com/watch.php?video=txqiwrbYGrs 3 Graba tus videos en con la Zx1 link: http://www.videos-star.com/watch.php?video=4-94JhLEiN0 4 Graba tus videos en con la Zx1 link: http://www.videos-star.com/watch.php?video=KYBF3HKzrmE 5 Graba tus videos en con la Zx1 link: http://www.videos-star.com/watch.php?video=XQcVllWpwGs Videos musicales 1 Graba tus videos en con la Zx1 link: http://www.videos-star.com/watch.php?video=E2tMV96xULk 2 Graba tus videos en con la Zx1 link: http://www.videos-star.com/watch.php?video=http://www.youtube.com/watch?v=NG2zyeVRcbs 3 Graba tus videos en con la Zx1 link: http://www.videos-star.com/watch.php?video=M11SvDtPBhA 4 Graba tus videos en con la Zx1 link: http://www.videos-star.com/watch.php?video=R7yfISlGLNU 5 Graba tus videos en con la Zx1 link: http://www.videos-star.com/watch.php?video=p_RqWocthcc [Estos son nada más algunos hay muchísimos más] 13 de marzo: lanzamiento en América y Europa de Resident Evil 5, para PlayStation 3 y Xbox 360, a los ocho días de haberse lanzado en Japón y el resto de Asia.[530] 2 de junio: lanzamiento mundial de Los Sims 3 para PC, Mac, iPhone, iPod touch y móviles. 22 de octubre: lanzamiento oficial del videojuego Pro Evolution Soccer 2010, para PlayStation 3, Xbox 360 y PC. 7 de diciembre: lanzamiento en Estados Unidos de The Legend of Zelda: Spirit Tracks para Nintendo DS. También faltó el Call of duty Modern warfare 2, Need for speed shift, fear 2, Prototype. Fútbol Campeonatos por selecciones * Campeonato Sudamericano Sub-20: 19 de enero al 8 de febrero: Bandera de Brasil Brasil se corona campeón. * Copa Confederaciones: 14 al 28 de junio: Bandera de Brasil Brasil se corona campeón. * Copa Mundial Sub-20: 24 de septiembre al 16 de octubre: Bandera de Ghana Ghana se corona campeón. *Copa Mundial Sub-17: 24 de octubre al 15 de noviembre: Flag of Switzerland.svg Suiza se corona campeón. Campeonatos internacionales * Liga de Campeones: el 27 de mayo, en el Estadio Olímpico de Roma, el equipo español Bandera de España FC Barcelona consigue su tercera copa al vencer por 2-0 al equipo inglés Bandera de Inglaterra Manchester United * Copa de la UEFA: el 21 de mayo, en el Estadio Sükrü Saracoglu, el equipo ucraniano Bandera de Ucrania Shakhtar Donetsk ganó su primera copa venciendo en la final al alemán Bandera de Alemania Werder Bremen. * Copa Libertadores: el 15 de julio, en el Estadio Mineirão, el equipo argentino Bandera de Argentina Estudiantes consigue su cuarto título al ganar al brasileño Bandera de Brasil Cruzeiro por 2-1, ya que el partido de ida, jugado el 8 de julio en el Estadio Ciudad de La Plata, había acabado con empate a 0. * Copa Sudamericana: el 2 de diciembre, en el Estadio Maracaná, el equipo ecuatoriano Bandera de Ecuador LDU Quito consigue su primer título al perder contra el brasileño Bandera de Brasil Fluminense por 3-0, ya que en el partido de ida, jugado el 25 de noviembre en el Estadio Casa Blanca, había ganado por 5-1. * Copa Mundial de Clubes: el 19 de diciembre, en el Estadio Sheikh Zayed, el equipo español Bandera de España FC Barcelona consigue su primera copa al vencer en la final por 2-1 al equipo argentino Bandera de Argentina Estudiantes de La Plata. FIFA World Player 2009: Lionel Messi. Después de dos años en el podio (07-08) Lionel Messi se hizo del FIFA World Player 2009 en el Kongresshaus de Zurich, para ser reconocido como el mejor jugador del mundo según votación de entrenadores y capitanes de las selecciones afiliadas a la FIFA, (aunque los brasileños no lo votaron en sendas ternas) con los siguientes resultados finales: Lionel Messi (Barcelona/Argentina) 1073 puntos, Cristiano Ronaldo (Manchester United - Real Madrid/Portugal) 352, Xavi (Barcelona/España) 196, Kaká (Milan - Real Madrid/Brasil) 190 y Andrés Iniesta (Barcelona/España) 134. Graba tus videos en con la Zx1 link: http://www.videos-star.com/watch.php?video=fsWzhqyVOsI Además del mencionado FIFA World Player, el premio al mejor jugador del Mundial de Clubes (FIFA), el Balón de Oro (France Football), Premio Alfredo Di Stéfano (MARCA), Premio al mejor Delantero y mejor Jugador de Liga (Federación Española de Fútbol) y Premio al mejor Delantero y mejor Jugador de la UEFA Champions League (UEFA). Un poco más. Los 10 descubrimientos científicos del año 2009 según Science La prestigiosa revista Science ha elegido al descubrimiento de Ardi, el esqueleto parcial fosilizado de una mona no arborícola que vivió hace 4.4 millones de años, como el logro científico más importante del año 2009. 1 ) Science afirma que el descubrimiento de Ardi (cuya reconstrucción podéis ver en la representación artística que ilustra este post) es el logro más significativo del año. El científico J. H. Matternes sostiene que el Ardipithecus ramidus fue uno de los primeros miembros de la rama humana del árbol genealógico de los primates, antecediendo a la famosa Lucy (encontrada en 1974) en más de un millón de años. Los otros nueve descubrimientos mencionados por Science en su lista son: 2 ) El descubrimiento de 16 púlsares – estrellas de neutrones que giran rápidamente – previamente desconocidos, por parte de un equipo internacional de astrónomos que emplearon el Telescopio Espacial de Rayos Gamma Fermi de la NASA. Este descubrimiento ha mejorado la comprensión que los físicos tienen de los fuertes campos magnéticos producidos por los púlsares. 3 ) El descubrimiento de que un compuesto llamado rapamicina prolonga la longevidad. La rapamicina – una secreción de una bacteria de suelo hallada en la Isla de Pascua – demostró ser capaz de prolongar la vida media de ratones de laboratorio entre un 9 y un 14 por ciento. 4 ) El desarrollo de dispositivos electrónicos experimentales hechos con grafeno (láminas de carbono del grosor de un solo átomo que se mueven increíblemente rápido). Este hallazgo permitirá crear dispositivos electrónicos muy finos, flexibles y extensibles. 5 ) El descubrimiento en las células de las plantas de receptores para el ácido abscísico, un compuesto químico que permite a las semillas permanecer latentes y que impide que las plantas pierdan agua durante los períodos de sequía. Explotar ese hallazgo podría mejorar las producciones de cosechas en tierras consideradas hasta ahora demasiado secas. 6 ) El primer laser de rayos-X, construido en el Laboratorio del Acelerador Nacional SLAC de Menlo Park, California. El LCLS (siglas para Fuente de Luz Coherente Linac) alimentado por una acelerador linear de tres kilómetros de longitud, puede tomar instantáneas de las reacciones químicas. 7 ) El uso de terapia génica para curar una rara enfermedad cerebral fatal, la ceguera hereditaria y un trastorno inmunológico llamado enfermedad del niño burbuja. 8 ) La creación de “quasi-partículas” con solo un campo magnético, que habían sido predichos por los modelos físicos pero nunca vistos en la naturaleza. Cada imán de los vistos hasta ahora tiene un polo norte y un polo sur, pero la teoría indicaba que los polos deberían ser capaces de existir por si mismos. Los físicos crearon los monopolos en una forma super-fría de la materia llamada hielo de espín. 9 ) La colisión deliberada del satélite de la NASA LCROSS (y sus cohetes tubulares agotados) sobre la luna el pasado mes de octubre, que confirmó la presencia de agua selenita. “No hay simplemente agua, sino mucho agua”, dijo Anthony Colaprete, científico del proyecto. 10 ) La reparación en órbita del telescopio espacial Hubble, realizado por la tripulación de la lanzadera Atlantis, que condujo a la consecución de las mejores imágenes tomadas en sus 19 años de historia. Durante 11 días y gracias a 5 paseos espaciales, los astronautas remplazaron la cámara, baterías y giroscopios del satélite, e instalaron nuevos instrumentos. Lo mejor y lo peor de 2009 "Lo extraordinario se hace cotidiano": Asesinatos, corrupción, basura, etc. Por primera, y casi seguro por última vez, este redactor se atreve a entregar los premios a lo mejor (peor) de 2009. Son galardones simbólicos pero entregados "con amorrrr". Ahí van: La pataleta del año: La del mismísimo hasta que logró la reelección indefinida. Por lo demás, explicada como una reafirmación de la Democracia, y una interpretación adecuada de la frase de Bolívar de "dejar permanecer a un magistrado por mucho tiempo en el poder, etc...", lo cual lo vuelve también el taumaturgo del año. El caído de la mata del año: Jesse Chacón, el único en Venezuela que no sabía que su hermano Arné había pasado de la pobreza a la opulencia, según dijo el presidente cuando Jesse le presentó su renuncia, "la cual aceptó". Mención honorífica para el mismísimo, que pese a saberlo todo y controlar todo, y decir que ni una hoja de un árbol se mueve sin su autorización en Venezuela, tampoco sabía lo de Arné. Espíritu deportivo de 2009: "Me la chupan y me la rechupan", Diego Maradona, en ocasión de la clasificación de Argentina al Mundial: hace con extrema dificultad algo que antes se obtenía sobradamente, y tras esos términos mínimos, cree que tiene derecho a exigir cualquier cosa. "El Diego" es chavista confeso, y así lo demuestra. La jalada del año: Jacqueline Faría , por "el dedo de Chávez es el dedo del pueblo". El dedo en el ojo se lo metieron a 700 mil caraqueños que votaron por Ledezma. Mención honorífica para la misma Jacqueline, por aquello de que los niños que fueran a las escuelas quitadas a la Alcaldía Mayor se convertirían en pequeños chavecitos; y para el Concejo Municipal de Libertador, que galardonó al presidente como "comunicador alternativo de 2009". Publicista del año: Ese que inventó que "lo extraordinario se hace cotidiano" en Venezuela. Asesinatos, corrupción, basura, inflación, caradurismo, etcétera. La purita verdad, pues. Cavernícola del año: Carlos Escarrá explicando el socialismo: cómo un consejo comunal fabricará tapitas, otro botellitas, un tercero azúcar y el cuarto el papelón. El quinto hará guarapo. A este ritmo, en cualquier momento reivindicamos la rueda o el fuego como logros bolivarianos y, por ello, a lo mejor Escarrá se sentirá con derecho a decir "me la chupan y me la rechupan". El adelantado a su tiempo de 2009: Es para Aristóbulo, quien afirma que "el mejor alcalde y el mejor gobernador es el que desbarate más rápidamente su gobernación y su alcaldía". Él, entre 1992-95, lo intentó en Libertador con éxito relativo, que ahora completa Jorge Rodríguez. Mención de honor para otro Rodríguez (San Juan), que hizo menos por Vargas que los deslaves. El peor ciego que no quiere ver de 2009: "Acabo de ver cómo reprimían a los jóvenes estudiantes, aquí en Copenhague. Una represión muy dura. Eso no sucede en Venezuela"... Bueno ahora comenzaré a hablar lo que pasó en Taringa durante este año, debo decir que se me puede escapar unas cuantas informaciones ya que recíen soy miembro desde julio de este año si no me equivoco TARINGA 2009 Sólo voy a hacer un breve resúmen de lo que pasó este año: No se me ocurre de dónde comenzar, pero comenzaré desde el gran top post del play 3, se armó un verdadero desastre cuando el sorteo era falso, todo taringa casi ponía en los comentarios "-Quiero me Play 3-", realmente me impresionó mucho la acción de este user que supuestamente ganó el play y luego sin ningún problema posteó una aclaración sobre este tema, no se enojó ni nada por el estilo, cuando cualquier persona se enojaría tanto que destrozaría la pc de su casa . Tambíen cabe mencionar cuando aparecía los scrip que todos copiaban y supuestamente se quedó hackeado taringa, acá les dejo una imagen mia [aclaro que no tengo orkut, es de un amigo] Los premios taringa 2009 de un User suicida que tenía que revisar cientos de MP Y si me faltaba, claro la nueva versión de taringa 4.0, donde aparecieron los nuevos emoticones y a casi nadie le gustó, casi todos querían la versión vieja de los emoticones que actualmente tenemos. TARINGA 4.0 dijo:Más información sobre: -Gripe AH1N1. -Más sobre película y vota el que mejor te gustó -Cierto me faltó el LHC [Detendrá su actividad hasta febrero del 2010] FUENTES FUENTE 1 FUENTE 2 FUENTE 3 FUENTE 4 FUENTE 5 FUENTE 6 FUENTE 7 FUENTE 8 FUENTE 9 Bueno eso fue todo por fin lo terminé, desde hace unos días ya estaba haciendo. Felices Fiestas a todos ACTUALIZACION: dijo:J9794 te falto: el grone se hace mascota de taringa xD dijo:pgmcanalla TE FALTARON VARIAS COSAS IGUAL COMO:Ç EL US OPEN QUE GANO DEL POTRO LA CLASIFICACION AL MUNDIAL,ETC

¿Qué son los Malwares? Malware es la abreviatura de “Malicious software” (software malicioso), término que engloba a todo tipo de programa o código de computadora cuya función es dañar un sistema o causar un mal funcionamiento. Dentro de este grupo podemos encontrar términos como: Virus, Trojan (Caballo de Troya), Gusano (Worm), Dialers, Spyware, Adware, Hijackers, Keyloggers, FakeAVs, Rogues, etc…. En la actualidad y dado que los antiguos llamados Virus ahora comparten funciones con sus otras familias, se denomina directamente a cualquier parásito/infección, directamente como un “Malware”. Todos ellos configuran el panorama del malware en la actualidad. Virus: dijo:Los Virus Informáticos son sencillamente programas creados para infectar sistemas y a otros programas creándoles modificaciones y daños que hacen que estos funcionen incorrectamente y así interferir en el funcionamiento general del equipo, registrar, dañar o eliminar datos, o bien propagarse por otros equipos y a través de Internet. Serian similares a los virus que afectan a los humanos ya que hay que implementar antibióticos en este caso serian los Antivirus. Normalmente, los virus más básicos sólo necesitan que un usuario desprevenido de un equipo los comparta o los envíe sin darse cuenta… Algunos virus más complejos, como los gusanos, pueden replicarse y enviarse por sí mismos de modo automático a otros equipos cuando consiguen controlar determinados programas de software, tales como aplicaciones de correo electrónico compartido. Ciertos virus, llamados troyanos, pueden presentarse bajo la apariencia falsa de un programa inofensivo para persuadir a los usuarios de que los descarguen. Existen troyanos que pueden incluso proporcionar los resultados esperados mientras, al mismo tiempo y de manera silenciosa, dañan el sistema del equipo y el de otros equipos en red. Cual es el funcionamiento básico de un virus? dijo:-Se inyectar y esconderse dentro del contenido de un archivo ejecutable (.exe., .com, .scr, etc) -Cuando el archivo ejecutable que contiene el virus es abierto por el usuario, intentará copiarse a otros archivos ejecutables para propagarse. -Pueden contener lo que se denomina como payloads: rutinas preparadas para ejecutarse ante ciertos eventos, por ejemplo, para mostrar mensajes, cambiar configuraciones del sistema o eliminar archivos, entre otras cosas. -Para propagarse a otras computadoras, un archivo ejecutable que contenga un virus debe ser transferido a través de algún medio, por ejemplo, un CD, disco flexible, un correo electrónico, etc. Cómo llegan? dijo: -A través de Internet, al visitar ciertas paginas webs donde están escondidos y prontos para infectar nuestro sistema con solo entrar en ellas. -A través del correo electrónico (e-mail): al ejecutar algún archivo que nos envían o pulsar en alguno enlace ofrecido. -A través redes de programas P2P en los que puedes descargarte música, programas, etc. -A través de disquetes, CD o DVD que hayan sido grabados de un equipo infectado por un virus. -A través de la Red Local de tu propia casa u oficina porque se pasan de un Pc a otro. Troyano: dijo:En la teoría, un troyano no es virus, ya que no cumple con todas las características de los mismos, pero debido a que estas amenazas pueden propagarse de igual manera, suele incluírselos dentro del mismo grupo. Un troyano es un pequeño programa generalmente alojado dentro de otra aplicación (un archivo) normal. Su objetivo es pasar inadvertido al usuario e instalarse en el sistema cuando este ejecuta el archivo "huésped". Luego de instalarse, pueden realizar las más diversas tareas, ocultas al usuario. Actualmente se los utiliza para la instalación de otros malware como backdoors y permitir el acceso al sistema al creador de la amenaza. Algunos troyanos, los menos, simulan realizar una función útil al usuario a la vez que también realizan la acción dañina. La similitud con el "caballo de Troya" de los griegos es evidente y debido a esa característica recibieron su nombre. Backdoors: dijo:Estos programas son diseñados para abrir una "puerta trasera" en nuestro sistema de modo tal de permitir al creador de esta aplicación tener acceso al sistema y hacer lo que desee con él. El objetivo es lograr una gran cantidad de computadoras infectadas para disponer de ellos libremente hasta el punto de formas redes como se describen a continuación. Adware: dijo:El adware es un software que despliega publicidad de distintos productos o servicios. Estas aplicaciones incluyen código adicional que muestra la publicidad en ventanas emergentes, o a través de una barra que aparece en la pantalla simulando ofrecer distintos servicios útiles para el usuario. Generalmente, agregan ícono gráficos en las barras de herramientas de los navegadores de Internet o en los clientes de correo, la cuales tienen palabras claves predefinidas para que el usuario llegue a sitios con publicidad, sea lo que sea que esté buscando. Que diferencia hay entre Adwares y Spywares? La diferencia esta en que suelen venir incluido en programas Shareware y por tanto, al aceptar los términos legales durante la instalación de dichos programas, estamos consintiendo su ejecución en nuestros equipos y afirmando que estamos informados de ello. Un ejemplo de esto pueden ser los banners publicitarios que aparecen en software diverso y que, en parte, suponen una forma de pago por emplear dichos programas de manera pseudo gratuita. Como entran en nuestras PCs? dijo:Estando ocultos en un programa gratuitos (Freeware) los cuales al aceptar sus condiciones de uso (casi siempre en ingles y que no leemos) estamos aceptando que cumplan sus funciones de mostrarnos su publicidad. Cuales son los síntomas de tener un Adware? dijo:Los Adwares se dedican a mostrarnos publicidades en los programas que estos vienen incluidos por medios de banners en estos, pero ya los mas peligrosos nos van a abrir ventanitas pop-ups por todas partes, van a agregar direcciones en los favoritos del IE y van a instalarnos barras de herramientas con el único objetivo de que naveguemos siempre dentro de sus redes de publicidad. Programas conocidos que incluyen Adwares dijo:Alexa, MyWebSearch, FlashGet, Cydoors, Gator, GoHit, Webhancer, Lop, Hotbar, eZula, KaZaa, Aureate / Radiate, RealPlayer, Zango, C2Media, CID, Messenger Plus etc… Spyware: dijo:El spyware o software espía es una aplicación que recopila información sobre una persona u organización sin su conocimiento ni consentimiento. El objetivo más común es distribuirlo a empresas publicitarias u otras organizaciones interesadas. Normalmente, este software envía información a sus servidores, en función a los hábitos de navegación del usuario. También, recogen datos acerca de las webs que se navegan y la información que se solicita en esos sitios, así como direcciones IP y URLs que se visitan. Esta información es explotada para propósitos de mercadotecnia, y muchas veces es el origen de otra plaga como el SPAM, ya que pueden encarar publicidad personalizada hacia el usuario afectado. Con esta información, además es posible crear perfiles estadísticos de los hábitos de los internautas. Ambos tipos de software generalmente suelen "disfrazarse" de aplicaciones útiles y que cumplen una función al usuario, además de auto ofrecer su descarga en muchos sitios reconocidos. Como entran en nuestras PCs? dijo:Al visitar sitios de Internet que nos descargan su código malicioso (ActiveX, JavaScripts o Cookies), sin nuestro consentimiento. Acompañando algún Virus o llamado por un Troyano Estando ocultos en un programa gratuitos (Freeware) los cuales al aceptar sus condiciones de uso (casi siempre en ingles y que no leemos) estamos aceptando que cumplan sus funciones de espías Que información nos pueden sacar? dijo:Pueden tener acceso por ej a: Tu correo electrónico y el password, dirección IP y DNS, teléfono, país, paginas que buscas y visitas y de que temas te interesan, que tiempos estas en ellas y con que frecuencia regresas, que software tienes y cuales descargas, que compras haces por internet y datos mas importantes como tu tarjeta de crédito y cuentas de banco. Los 5 principales síntomas de infección son: dijo:Se nos cambian solas las pagina de inicio, error y búsqueda del navegador. Se nos abren ventanitas pop-ups por todos lados, incluso sin estar conectados y sin tener el navegador abierto, la mayoría son de temas pornográficos. Barras de búsquedas de sitios como la de Alexa, Hotbar, etc.. que no podemos eliminar. Falsos mensajes de alerta en la barra de Windows (al lado del reloj) de supuestas infecciones que no podemos eliminar y/o secuestro del papel tapiz de nuestro escritorio. La navegación por la red se hace cada día mas lenta, en varias ocasiones nunca se llega a mostrar la pagina web que queremos abrir. Dialer: dijo: Tratan de establecer conexión telefónica con un número de tarificación especial. Hijacker: dijo:Se encargan de “Secuestrar” las funciones de nuestro sistema cambiando la pagina de inicio y búsqueda y/o otros ajustes del navegador. Estos pueden ser instalados en el sistema sin nuestro consentimiento al visitar ciertos sitos web mediante controles ActiveX o bien ser incluidos por un troyano. Joke: dijo:Gasta una broma informática al usuario. Rootkit: dijo:Es un conjunto de herramientas usadas frecuentemente por los intrusos informáticos o crackers que consiguen acceder ilícitamente a un sistema informático. Estas herramientas sirven para esconder los procesos y archivos que permiten al intruso mantener el acceso al sistema, a menudo con fines maliciosos. Hay rootkits para una amplia variedad de sistemas operativos, como Linux, Solaris o Microsoft Windows. Por ejemplo, el rootkit puede esconder una aplicación que lance una consola cada vez que el atacante se conecte al sistema a través de un determinado puerto. Los rootkits del kernel o núcleo pueden contener funcionalidades similares. Herramienta de Hacking: dijo:Permite a los hackers realizar acciones peligrosas para las víctimas de los ataques. Keylogger: dijo:Aplicaciones encargadas de almacenar en un archivo todo lo que el usuario ingrese por el teclado (Capturadores de Teclado). Son ingresados por muchos troyanos para robar contraseñas e información de los equipos en los que están instalados. Hoax: dijo:Son mensajes de correo electrónico con advertencias sobre falsos virus. Spam: dijo:Es el envío indiscriminado de mensajes de correo no solicitados, generalmente publicitarios. FakeAVs & Rogues: dijo:Básicamente un Rogue software es un falso programa que nos mostrara falsos resultados de nuestro sistema ofreciéndonos a la vez pagar por este para que se encargue de repararlo. Por supuesto que esto es todo totalmente falso y el único objetivo es el de engañar al usuario a comprar su falso producto. Entre los mas destacados están los FakesAVs (Falsos Antivirus) y FakeAS (Falsos Antispywares) de los cuales en InfoSpyware venimos llevando desde el año 2005 un listado de la mayoría de estos y que pueden ver en Listado de Falsos Antivirus – AntiSpyware y Rogue Software. Que es un Falso Antivirus / Antispyware? dijo:Se le denomina Rogue Software (o también Rogue, Rogueware, FakeAVs, Badware, Scareware) a los “Falsos” programas de seguridad” que no son realmente lo que dicen ser, sino que todo lo contrario. Bajo la promesa de solucionar falsas infecciones, cuando el usuario instala estos programas, su sistema es infectado. Estos falsos Antivirus y Antispyware están diseñados para mostrar un resultado predeterminado (siempre de infección) y no hacen ningún tipo de escaneo real en el sistema al igual que no eliminaran ninguna infección que podamos tener. LISTADOS DE FALSOS ANTIVIRUS ACTUALIZADOS MAS INFO Rootkits FUENTES 1/2/3

Creo que hay muchas personas que no quieren leer pero les podría resultar interesante. Hola gente de taringa, posteo esto para distraerse un poco y ver algunos consejos, reflexiones, y todo eso. Posiblemente le resulte interesante a algunos y a otros quizás no pero bueno les dejo con el post. PARA EMPEZAR Tipicos Pensamientos Humanos Tal vez sea la razón por la que los humanos nunca son felices completamente..... Reflexion. Hacia frio. Mientras caminaba hacia mi paradero, me cruce con una chica que tenia una cara muy seria. No era que estaba seria, su rostro era severo, como si estuviera molesta siempre. Luego con un hombre con el miedo en su cara. Mirando hacia atrás, pensé que tal vez era perseguido por alguien. O que pensaba que todo el mundo le miraba. Para luego pasar al lado de una chica sonriendo. Se la veia contenta. ¡Bien por ella! Mas adelante una pareja conversaba animadamente. El amor. Se sonreian mutuamente, y se veia un interés mutuo Unos pasos más adelante un anciano caminaba lentamente, y de vez en cuando miraba al cielo. Aun no, amigo, aun no. Llegué al paradero. Una chica conversaba por celular, se le notaba discutiendo con la otra persona. Al frente dos señoras se reian, seguro de una broma que una de ellas contaba. Mientras subia al colectivo para ir a casa, pensé, que la vida es bella. Siempre hay Uno Que No Quiere Ver Siempre lo hay. Quien predice el futuro, quien dice, que no va a durar, que no va a servir. Los hechos demuestran que si vas contra el futuro, seas lo que seas, vas a perder tu apuesta.(VER EN TAMAÑO COMPLETO) Reducir El Estres en el Trabajo El lugar de trabajo puede ser un lugar estresante. Si te encuentras demasiado cansado y fácilmente irritable, puede ser debido a estres en el trabajo. Incluso eso conduce a que no puedas disfrutar el tiempo fuera del trabajo, debido que estas demasiado cansado para hacer las cosas que quieres hacer. Aquí unos cuantos consejos para reducir el estrés y hacerte la vida un poco más fácil en el trabajo. Cosas que hacer en el Trabajo: Llegar a tiempo: de hecho llegar un poco más temprano si puedes. Date la oportunidad de tener unos momentos en calma, o incluso adelantar un poco ese trabajo importante, sin que tus compañeros de trabajo te interrumpan. Asi tu dia puede ser un poco más fácil. Personaliza tu lugar de trabajo: unas fotos o imagenes que te hagan sonreír, tal vez una pequeña planta o dos, o unas cuentas frases ingeniosas u ocurrentes en tu computadora. Si tu espacio de trabajo mejora, te sentirás mejor, y te autoinvitaras a trabajar a gusto en él. Evita a las personas negativas: probablemente trabajas con alguien que para quejandose, o que tiene actitudes negativas, trata de no ser igual, una actitud positiva es la mejor manera de eliminar el estrés en el trabajo. Sonrie, y Se Feliz: siempre va a haber algo que te preocupe o moleste. Si no es una cosa, es otra. Pero si sonries, haces bromas y ries, tu mal humor se disipara, provocando que te sea más fácil cumplir con ese feo proyecto o esa tarea incomoda. Incluso, una sonrisa falsa, puede disparar una verdadera, liberando endorfinas y hormonas de la felicidad en tu cuerpo. Mantente sonriendo y siendo feliz. Si algo te molesta, no explotes de inmediato. Trata de calmarte. Respira profundamente y trata de respirar solo por la nariz, y trata de respirar cada vez más lentamente. Aguanta la respiración un momento. Da un paseo, o alejate del lugar donde pasó el problema. Date tiempo para limpiar tus pensamientos, e incluso puedes retornar con un plan para solucionar el problema, y sintiendote menos molesto. Trabaja sobre tus habilidades de administración del tiempo: planea tu dia, toma proyectos una vez a la vez. Es mas facil permanecer enfocado e una sola cosa, y dejar lo otro para después, cuando puedas encargarte de ello. Di NO: si tienes demasiada carga, esta bien dejar de ayudar a alguien en otro proyecto. Hazlo de buena manera: "me encantaría ayudar, pero tengo varias cosas para hacer". Practica decir que no, especialmente si te das cuenta que cuando dices que si, te arrepientes. Cosas que hacer en Casa Duerme lo suficiente. Esto es muy dificil, especialmente cuando tienes una agenda muy ocupada. Pero si haces algunos ajustes, de modo que puedas dormir bien, tendrás la energía necesaria para cumplir tus metas. Come bien. Puedes y deberias incluso hacer esot en el trabajo también. La comida rápida o grasos, no provee de las calorías necesarias ni la energía para tu cuerpo. De hecho, sé estricto comiendo bien por una semana. Notarás una buena diferencia si comes algo en ese fast food en las siguientes semanas. No te sentirás tan bien cmo si hubieras elegido comer fruta, un sanguche casero o pan integral. En vez de eso, esa comida te sentirá como una piedra en tu estomago, y puede enfermarte. Haz ejercicios regularmente. Solo 20 minutos de ejercicio algunas veces a la semana, incrementarán tu energía. Parece ser una contradicción, pero mientras más ejercicio hagas, tu resistencia aumentará, y tus niveles de energía también. Encuentra una rutina que puedas seguir. Evita el alcohol y la nicotina. Es comén que la gente encuentre estas cosas como herramientas de relajación, pero realmente dañan tu cuerpo y tu salud, teniendo un impacto directo sobre tu energía y niveles de estrés en el trabajo. No está demás tomar unas copas en una celebración, pero no es algo que deba hacerse todos los días o todas las semanas. La nicotina del cigarro, en vez de ser un calmante, es un estimulante, que incrementa la ansiedad. Conclusión Mientras que todos estos pasos pueden ayudarte, no aumentes tus niveles de estrés tratando de seguir todas esas recomendaciones a la vez. Si crees que puedes, hazlas, pero si tienes dificultades solo empieza una a la vez. La vida no se disfruta cuando vamos a toda velocidad y tratamos de hacer todo en un momento. Piensa como un Millonario Si fueras un millonario, la vida podría ser muy sencilla. ¿Verdad? Si eres como yo ya estarás pensando en todas las cosas que podrías hacer, comprar, y disfrutar, claro mientras desapareces todas tus deudas en un solo movimiento bancario. Libre de deuda, y viviendo la buena vida. Aunque parezca algo difícil de lograr por el momento en que estás, los millonarios no son tan diferentes que nosotros. Los diferencia en que ellos piensan como millonarios. Entonces ¿cómo se lograr pensar como millonario si no lo eres? No importa en realidad como llegas a lograr esa meta. Puedes soñar con un buen fondo de jubilación, o puedes empezar un negocio propio y puedes vivir confortablemente los próximos años. Puede ser que desees ser realmente un millonario o simplemente la flexibilidad de poder renunciar a tu trabajo formal y dedicarte a tu afición favorita a tiempo completo. Tienes que empezar a creer que eso es posible. Redirige tus pensamientos, cambia tu perspectiva, etc. Si empiezas esperando fallar.....entonces fallarás. Una actitud positiva tiene mucho mayor efecto de lo que podrías imaginar. Tienes que empezar a creer que eso es posible. Redirige tus pensamientos, cambia tu perspectiva, etc. Si empiezas esperando fallar.....entonces fallarás. Una actitud positiva tiene mucho mayor efecto de lo que podrías imaginar Evita la negatividad tanto como sea posible. Ignora la negatividad, y alejate de la gente que está determinada a convencerte que tu fracaso es inevitable. Esa gente siempre tiene esa mentalidad y no quiere ver a otros tener éxito o intentar lograr mejores cosas. No puedes dejar a nadie que te convenza que no es posible que logres tus metas. Tienes que invertir mucho tiempo y dinero, y en realidad tienes que invertir mucho de esas dos cosas. Pero sin llegar a estresarte y obsesionarte con lograr tu meta, tienes que dedicar una cantidad significante de tiempo en el proceso. Habrán tropezones, y fallos en el camino. Aprende de ellos, y continua. A veces un incidente que te perjudique, puede convertirse en una idea que hará una contribución al esfuerzo de lograr tu meta. Si llegas a ver esos momentos negativos como oportunidades más que obstáculos, será mucho más fácil mantenerte en la ruta al éxito. Cambia tu pensamiento a largo plazo. A menos que ganes la lotería mañana, se necesita tiempo para construir riqueza. No puedes establecer metas inalcanzables a corto plazo, porque te decepcionarás a ti mismo. Establece objetivos a un plazo prudente y lo suficientemente lejano para que cuentes con el tiempo para llevar a cabo todos los pasos necesarios. Si los objetivos a corto plazo te parecen mejor para mantenerte en el camino, asegurate que sean razonables, y posibles de lograr. Fíjate una fecha limite, pero no te desanimes si encuentras que necesitas más tiempo para lograr el objetivo. No te rindas. Apasionate sobre el hecho de ser millonario. Si realmente no te interesa tener un negocio propio no hay forma en que llegues a ser un millonario con un negocio. Talvez una cuenta con altos intereses puede ser el camino que te convenga y se adecue a tu personalidad. Encuentra el camino hacia tu objetivo, de modo que ese camino sea agradable para ti. Si sigues tu pasión, si es lo que te gusta, el camino a ser millonario, la forma que elijas como serlo, será más sencilla de llevar. ¿El Dinero Puede Comprar la Felicidad? El dinero puede comprar la felicidad. Claro, no hay ninguna tienda donde puedes comprar la felicidad directamente, ya sabes, es dificil mantener un inventario sobre un intangible tan subjetivo. Pero lo que tu puedes comprar con el dinero tiene un efecto directo y medible sobre tu nivel de felicidad. Algo como el viejo dicho dice: "el dinero no compra la felicidad pero puede comprar algo parecido". Vamos viendo algunas cosas en que podemos gastar nuestro dinero, y que se convierte en una inversión para nuestra felicidad. I.Gastar Dinero en Otros Se sabe que cuando las personas gastan dinero en otros, ellos se sienten más felices que si hubieran comprado las mismas cosas para ellos mismos. Para algunas personas, destinar dinero para otros puede ser cuestionable o dar una sensación de pérdida dependiendo de la cantidad fastada. Pero en realidad, el resultado de comprarle cosas a otra persona o gastar dinero en ella, resulta creando felicidad en la persona que gasta o compra. Cuando haces donaciones, te sientes feliz porque sabes que hay personas que recibirán una valiosa ayuda a la que contribuiste. Comprarle un regalo a un amigo o un familiar, hará que el rostro del ser querido se ilumine, lo que es una recompensa mucho mayor a la que sentirás si sólo compras para ti mismo. II. Compra una Experiencia Las personas que gastan dinero en una experiencia también reportan sentimientos felices que si ellos compraran cosas materiales. Incluso los souvenirs que se compran durante un viaje o excursión no parcen traer tanta felicidad como los recuerdos adjuntos a ellos. Puedes revivir memorias una y otra vez y la experimentar dichas emociones sin cansarte de ello, en contraparte con posesiones materiales que eventualmente se deterioran, o que te aburriran en un tiempo. La experencia a comprar no tiene que ser unas vacaciones extraordinarias que traiga la felicidad. Un pequeño gesto como ir a cenar fuera con un amigo sobre una noche estresante, cuando solo realmente necesitas hablar, puede traer mas felicidad que si ese amigo te compre un regalo o una tarjeta. III. Invertir Internamente Si gastas dinero directamente en ti mismo en un intento por lograr la felicidad, conseguirás grandes resultados si tu gastas en algo que te beneficiará por un periodo largo de tiempo. Por ejemplo, si inviertes en ejercicios y en comer saludablemente, te sentirás mejor fisicamente lo que redundará en sentirte mucho mejor emocionalmente. Nunca subestimes los efectos positivos de tratarte a ti mismo bien. Si comes un monton de comida basura regularmente, trata de comer bien por una semana y notarás como te sientes mucho mejor. Y no hay nada que se compare al sentimiento de logro y triunfo cuando finalizamos una rutina de ejercicios. El dinero no compra la felicidad, si es que constantemente buscamos más y más dinero y nos centramos en una espiral interminale de compras. Si incrementas tus ingresos, tu dinero simplemente encuentra otro lugar por donde desaparecer y volverás al mismo punto, sintiendote miserable y volviendo a establecer una nueva meta monetaria. Trata de no pensar en el dinero mismo. En vez de eso, considera la experiencia que buscas y los resultados que producirá para ti mismo o para alguien más. Luego coloca el dinero necesario en esa experiencia, y la felicidad vendrá por ahí. Si el Mundo fuera una Aldea de 100 Personas John Chow ha publicado un vídeo de The Miniature Earth Project donde se explica como se distribuiría la población de la tierra si solo fuera una aldea de 100 personas. El mundo es un lugar muy, pero muy grande, y los números cuando se expresan en millones o miles de millones son difíciles de entender para cualquiera. Es decir, no podemos imaginarnos una situación correctamente cuando alguien habla de miles de millones de personas. Seis mil millones de personas viven actualmente en la tierra. ¿Se imaginan y entienden ese número? En este vídeo nos ilustran como seria el mundo si solo fuera una aldea de 100 personas, para entender y apreciar lo que tenemos: Link del video porque no es de youtube y no se puede poner. Si pudiéramos hacer que la población de la tierra se resuma en 100 personas, manteniendo las mismas proporciones que tenemos hoy en día, podría ser algo como esto.... 61 asiáticos 12 europeos 8 norteamericanos 5 de sudamerica y el caribe 13 africanos 1 de Oceanía 50 mujeres 50 hombres 47 vivirían en zonas urbanas 9 son discapacitados 33 son cristianos (católicos, protestantes, ortodoxos, anglicanos y otros) 18 son musulmanes 14 son hindúes 16 no profesan ninguna religión 6 son budistas 13 practican otras religiones 43 viven sin cuidados de salud básicos 18 viven sin una fuente de agua mejorada 6 personas poseen el 59% de la riqueza entera de la comunidad 13 padecen de hambre o son mal nutridos 14 no saben leer Solo 7 tienen educación secundaria Solo 12 tienen una computadora Solo 3 tienen conexión a internet 1 adulto entre 15 y 49 años tiene VIH/SIDA Esta aldea de 100 personas gasta 1.12 trillones de dolares en gastos militares Y solo 100 billones de dolares en apoyo social Si guardas tu comida en un refrigerador, tu ropa en un closet, tienes una cama para dormir en ella y un techo sobre tu cabeza eres más rico que el 75% de la población mundial Si tienes una cuenta bancaria eres uno de las 30 personas mas ricas en el mundo 18 luchan para vivir con un dolar por día o menos 53 luchan para vivir con dos dolares por día o menos Aprecia lo que tienes Y haz lo mejor para lograr un mundo mejor Momento de Reflexión Un profesor que estaba dando una clase sobre como manejar el estres en la administración, tomó un vaso de agua y preguntó: "¿Que tan pesado es este vaso?" Las respuestas variaron entre 20 a 500 gramos. El profesor respondió: "No importa el peso. Depende cuanto tiempo trates de sostenerlo." "Si lo sostengo por un minuto, no es ningún problema." "Si lo sostengo por una hora, seguramente mi brazo me dolerá." "Si lo sostengo por un día, ustedes tendrán que llamar a una ambulancia." En cada caso es el mismo peso, pero mientras más lo sostenga, más pesado se volverá. Y lo mismo pasa con el estrés. Si siempre llevamos nuestras cargas todo el tiempo, pronto o tarden, esas cargas se volverán muy pesadas, y no podremos sobrellevarlas. Como el vaso de agua, tienes que ponerlas a un lado, por un momento y descansar. Cuando hemos descansado y estemos frescos, volvamos a tomarlas. No importa las cargas y responsabilidades que tengamos, pongamolas a un lado por un momento. Relajate, descansa, antes de volverlas a tomar. Vive simple, ama generosamente, precoupate enteramente, y habla con amabilidad, y sé lo mejor para tí mismo. Un poco más. No Pongas los Codos encima de la Mesa ¡No Molestes! Supuestamente es de mala costumbre colocar los codos encima de la mesa cuando vas a comer. Y digo supuestamente porque a mi me parece muy incomodo comer de esa manera, y no sé porque una buena costumbre nos debe incomodar en vez de facilitarnos el comer. Seguro que esa "regla de la buena educación" fue establecida por alguien que recibia muchos codazos en la mesa a la hora de comer. Recomendación: pon tus codos donde quieras, cuando comas, debes estar comodo. Y si alguien te viene a molestar, diciendo que es de mala educación, usa tu codo, esta vez para golpear su cara. 5 Consejos de Arnold Schwarzenegger Para Construir La Vida Que Deseas 1.Creer en Ti Mismo. "Yo sabía que era un ganador, estaba destinado para grandes cosas. Las personas dirán que esa clase de pensamiento es totalmente falto de modestia. Estoy de acuerdo. La modestia no es una palabra que se pueda aplicar a mi persona, y espero que nunca lo sea." 5 Consejos de Arnold Schwarzenegger Para Construir La Vida Que Deseas "Tenemos un gran poder dentro de nosotros. El poder es la fe en uno mismo. Hay una actitud de ganar. Tienes que verte ganando antes de ganar. Y tienes que estar hambriento de triunfos. Tienes que desear conquistar." "La mente es el limite. Si en tu mente puedes tener la visión de que es un hecho que tu puedes lograr algo, tu puedes hacerlo, mientras creas en ello al 100%." Una fuerte confianza en uno mismo es muy util. Tan sencillo como suena, de creer en nuestra determinación en que nuestro viaje nos llevará al destino que queramos. Sin embargo, es una frase similar a "cree en ti mismo", que viene sin instrucciones de como lograrlo. Aqui unas cuentas para lograrlo: Primero, tienes que manejar las cosas negativas que encontrarás en tu camino, pensando y creyendo que vas a poder superarlas. Establece metas y logralas, de ese modo la confianza en ti mismo crecerá. No parece ser una forma sencilla o glamorosa. Tienes que pasar mucho tiempo en eso y mucho esfuerzo para lograrlo. Debemos ver que vamos a encontrar dificultades, y no dejar que un error o fallo nos derrote completamente y nos quite confianza en nosotros mismos. Tenemos mucho potencial, y debemos pensar en nosotros como nuestro mejor activo. 2. Mirar los fracasos y errores como algo positivo. "La fuerza no viene de los triunfos. Tus derrotas desarrollan tu fortaleza. Cuando atraviesas dificultades y decides no rendirte, eso es tener fuerza." 5 Consejos de Arnold Schwarzenegger Para Construir La Vida Que Deseas El fallo no es el fin del mundo. Es parte del viaje. Una parte de la curva de aprendizaje. Si tenemos una mentalidad fatalista, un problema o dificultad nos hará creer que el cielo se cae. Tenemos que meternos la idea, que siempre habrá más oportunidades. Hay que cambiar la mentalidad. La mentalidad la podemos cambiar si cambiamos lo que nos ingresa, noticias, publicidad, con información útil y positiva, por ejemplo de autores de desarrollo personal. Otra forma es juntarse con gente que tenga esa mentalidad. En realidad, nosotros fallamos solo cuando nos rendimos. Aprendamos de nuestros errores y fallos, de tal manera que podamos ir modificando nuestra forma de vivir, y tomar un mejor camino hacia nuestras metas. 3. El esfuerzo extra. "Los últimos tres o cuatro movimientos es lo que hace que el musculo crezca. Esa area de dolor divide al campeón del que no lo es. Ahi es donde la mayor parte de la gente abandona, teniendo la oportunidad de avanzar un poco mas y avanzar a traves del dolor sin importar lo que suceda." 5 Consejos de Arnold Schwarzenegger Para Construir La Vida Que Deseas Ese esfuerzo extra. Si, cuando a veces parece una pequeñez, pero sabemos que nos causará dolor pero vemos el triunfo después. Muchos nos rendimos en ese escalon, atravesamos la mayor parte de la escalera, y cuando ya no damos más, nos damos cuenta que necesitamos subir un par de escalones más. La decisión y la duda. A veces lo pensamos demasiado, tanto que nos rendimos. Solo debemos hacerlo, solo debo hacerlo, sin pensarlo. 4.Entrenar "El entrenamiento nos da salida a energías reprimidas creadas por el estres y esto entona el espiritu de la misma forma que el ejercicio entona el cuerpo." Dicen que el ejercicio es una de las mejores formas para quitar el estres, cuando uno esta ansioso, nervioso o negativo, ir a hacer ejercicios es lo mas relajante que pueda haber. Cuando uno hace ejercicios, se concentra en eso y vamos olvidando un poco los problemas, y le damos a la mente un descanso merecido. 5.Ayuda a otros "Ayudar a otros es dar algo de vuelta. Garantizo que descubriras que el servicio a la comunidad mejora las vidas y el mundo de los que estan alrededor tuyo, y su mas grande recompensa es el enriquecimiento y nuevo significado que le traerá a tu propia vida." Aparte de lo que Arnold dice que recibiremos a cambio de ayudar a otros, tambien creamos muchas relaciones personales y laborales. Es la ley de reciprocidad, que alienta a dar algo a cambio en las personas. Si provees valor y ayuda a ellos, luego recibiras una mano cuando la necesites. 25 Tips para ser mas productivo y feliz en el trabajo 1. Interrogante perenne. Mantener un papel en tu escritorio con las siguientes preguntas para mantenerte enfocado: ¿Estoy haciendo lo correcto con mi tiempo? ¿Este es el uso mas productivo para mi tiempo? Si estás ocupando tu tiempo en cosas inutiles o dañinas, ocupa tu tiempo en algo mejor. 2. Aceptar que nunca terminarás tu lista de tareas. Esto es inaceptable para los perfeccionistas, pero de esa lista de tareas debes dejar para despues lo que no es importante, enfocate en las prioridades. 3. Apaga tu computadora. ¿Qué? Piensa, ¿realmente todo lo tienes que hacer con tu computadora? Apartate de ella y planea el uso del la Pc por una fracción del día, así también descansará tu vista. 4. Que el chequear el correo no se la primera cosa a hacer del día. A menos que sea requerido por tu trabajo, no chequees el correo hasta que hayas terminado con tus prioridades del día. Programate para leer el correo solamente cada 2 o 3 veces al día. 5. Tomate un descanso. Haz una pausa, es un hecho que tomar pequeños descansos aumenta la productividad. 6. Aprovecha el camino al trabajo. Haz de él un tiempo positivo. Usalo para leer, escribir, pensar creativamente, escuchar audiolibros, o escribir tu propio libro, si disfrutas el camino al trabajo, tu felicidad dentro del trabajo aumentará. 7. Planea. Establece una rutina para planear tu día o tu semana. Tomate unos 15 minutos para planear tu día. Utiliza una parte de la mañana del domingo para planear tu semana. Solo cosas importantes, no detalles demasiado. 8. Elimina tareas sin importancia. Quita los items no esenciales de tu lista de cosas por hacer. Para hacer esto, primero termina las cosas importantes, milagrosamente lo no esencial se autopostergará. 9. Transiciones. Utiliza tu tiempo efectivamente entre reuniones y actividades. 10. Elije felicidad, humor, entusiasmo, gratitud,amabilidad, y una perspectiva positiva. Ser competitivo y efectivo en el trabajo no quiere decir que siempre hay que ser serios. Sonreír no quiere decir que no estes trabajando. Entusiasmo no quiere decir que no eres competitivo. Siendo positivo no quiere decir que no aceptes ningun reto. Elije disfrutar tu tiempo en el trabajo. Acercate a quienes aplauden esto y alejate de los que susurran negatividad. 11. Cultiva compasión con tus compañeros de trabajo con actitud negativa. Ellos deben tener algun problema y hay que tratar de ser una buena influencia para ellos. 12. Ten paz contigo mismo, especialmente en esos días malos. Ve lento, una cosa a la vez, y mantente moviendote hacia adelante. 13. Toma cada cosa como un paso. Fechas limite, jefes hostiles, clientes rudos,computadoras lentas. Asi es el mundo, mantente en movimiento, y siempre hacia adelante. 14.Conflictos con otros. Establece que tu meta sea lograr progreso. No es ganar al otro, sino conseguir progresar ambos. 15. Toma vacaciones. Y trata de hacerla diferente. La variedad es una de las claves de la felicidad. 16. Elije tus batallas. Elije al oponente correcto, sino estarás perdiendo tiempo en cosas sin importancias. 17. Comparte tus resultados. No quiere decir que fanfarrones pero haz que la gente se entere de los resultados de tu duro trabajo, ellos no pueden saberlo, haz saber a la gente correcta tu contribución al éxito de la compañía. 18. Pide ayuda. No temas pedir ayuda a otros, no esperes que tu compañia te diga que hagas eso. Un trabajo en equipo contribuye mas al exito de la compañia. 19. Da la cara a las cosas dificiles. Cuenta hasta tres y lanzate, no esquives el bulto, haz la cosa mas dificil o aburrida primero, al comienzo del día y asi evitarás pensar en ella el resto del dia. 20. Pide mas tiempo. Si no sabes la respuesta en este momento, pide tiempo para investigar y regresar con la mayor información disponible. 21. Rompe los habitos negativos. Analizate. Cual es tu mayor problema? Con quienes? Con quien? En que circunstancias? Resuelvelo, no hoy, pero si a mediano plazo. 22. Aprende de las criticas. No rechaces las criticas, siempre traen algo de verdad, aprende de ellas para mejorar. 23. Adaptate. Los que no se adaptan se extinguen. Abrete al cambio. Date una oportunidad. 24. Aprende y Mejora. Mantente en las busqueda de apredner nuevas habilidad y mejorar las que ya tienes. Asi mantienes tu entusiasmo. 25. Pensar creativamente. Es tu trabajo aburrido? Es tu responsabilidad cambiar eso...puedes hacerlo mas creativo? mas divertido? mas variado? que puedes hacer que nadie haya hecho antes? Busca nuevas formas de hacer las cosas de siempre. 10 Razones para Empezar Tu Propio Negocio 1.Ser Tu Propio Jefe Si. Se acabó tener que recibir ordenes del pesado de tu jefe. ¿Te tiene enfermo tu jefe con tantas cosas que te asigna? Si empiezas tu propio negocio, serás el jefe, el gerente, el dueño, y también el empleado. Tu estableces las tareas a hacer y en que tiempo las harás. ¡Excelente! 2.Te interesará mas que tu trabajo diario Si es tu propio negocio, va a ser algo en el que estás muy interesado y te gusta hacer. Entonces estarás haciendo algo que te agrada, y mejor aún puedes convertirlo en dinero. 3.Plazos de tiempo y fechas limite En un trabajo normal, tu jefe te establece los plazos de tiempo. "En una hora ya tiene que estar instalado ese equipo". Y no le importa si es que dicho equipo necesita por lo menos un par de horas más. Si es nuestro negocio, nosotros ponemos las fechas limite. Claro que tampoco hay que extralimitarnos, si el cliente necesita el trabajo terminado para una fecha, hay que calcular si podemos cumplir con dicho plazo y cumplir con el cliente. 4.Tu forma de hacer las cosas Cuando es tu negocio, tu haces las cosas en la forma que deseas. Tienes la libertad de escoger el procedimiento a tu criterio. Pero, aunado a eso, debes estudiar bien las posibles consecuencias de elegir ciertos pasos. 5.No es tan difícil Puede que algunos términos como llevar la contabilidad del negocio nos asusten, pero no es tan difícil como algunos creen. Hay que investigar, y aprender, en ocasiones, según el tipo de negocio, solo necesitamos llevar unos cuantos registros. 6.Negocio Rentable Cuando uno empieza el negocio propio, las cosas se ven color de hormiga. So largas horas de trabajo, seguidas de muy poco dinero, pero a largo plazo, ser el dueño de tu propio negocio es muy rentable. Si conduces bien tu negocio, la recompensa es muy grande. 7.Un trabajo diferente Una gran ventaja de ser el dueño de tu propio negocio, es que puedes hacer diferentes cosas en él. Es muy diferente del monótono trabajo de horario fijo. Te da la libertad de aprender nuevas cosas, que podrían significar mejoras para ti. 8.No tienes que tener un local y no te mueves de tu casa Tu negocio puede tener como primer local tu casa. Puedes ahorrar un poco más, ya que no tienes que estar tomando taxi o colectivo hacia tu centro de trabajo. 9.Lo mejor de ambos mundos Claro, si al principio te das cuenta que el negocio no da para proporcionar un ingreso regular, puedes seguir en el trabajo regular, mientras manejas tu propio negocio. Hay mucha gente con un trabajo regular y un negocio online a la vez. Un negocio online paralelo es más sencillo, ya que se pueden automatizar muchas tareas. Para hacer un negocio online un éxito, debes elegir un tema que realmente te guste, por ejemplo algo a lo que seas aficionado. 10.Sueños La ventaja de ser el dueño de tu propio negocio es que tus sueños puedes volverlos realidad. Sea que tu sueño sea del tipo financiero, o solo tener más tiempo en casa, ser empresario es la forma de lograrlo. En tu trabajo regular casi nunca consigues eso. Si quieres cumplir tu sueño, empieza un negocio propio. Una Bella Lección de Vida (ESTO YA LO HABÍA POSTEADO EN OTRO POST PERO IGUAL CREÍ QUE NO DEBÍA FALTAR) Un estudiante universitario salió un día a dar un paseo con un profesor, a quien los alumnos consideraban su amigo debido a su bondad para quienes seguían sus instrucciones. Mientras caminaban, vieron en el camino un par de zapatos viejos y supusieron que pertenecían a un anciano que trabajaba en el campo de al lado y que estaba por terminar sus labores diarias. El alumno dijo al profesor: Hagámosle una broma; escondamos los zapatos y ocultémonos detrás de esos arbustos para ver su cara cuando no los encuentre. Mi querido amigo -le dijo el profesor-, nunca tenemos que divertirnos a expensas de los pobres. Tú eres rico y puedes darle una alegría a este hombre. Coloca una moneda en cada zapato y luego nos ocultaremos para ver cómo reacciona cuando las encuentre. Eso hizo y ambos se ocultaron entre los arbustos cercanos. El hombre pobre, terminó sus tareas, y cruzó el terreno en busca de sus zapatos y su abrigo. Al ponerse el abrigo deslizó el pie en el zapato, pero al sentir algo adentro, se agachó para ver qué era y encontró la moneda. Pasmado, se preguntó qué podía haber pasado. Miró la moneda, le dio vuelta y la volvió a mirar. Luego miró a su alrededor, para todos lados, pero no se veía a nadie. La guardó en el bolsillo y se puso el otro zapato; su sorpresa fue doble al encontrar la otra moneda. Sus sentimientos lo sobrecogieron; cayó de rodillas y levantó la vista al cielo pronunciando un ferviente agradecimiento en voz alta, hablando de su esposa enferma y sin ayuda y de sus hijos que no tenían pan y que debido a una mano desconocida no morirían de hambre. El estudiante quedó profundamente afectado y se le llenaron los ojos de lágrimas. Ahora- dijo el profesor- ¿no estás más complacido que si le hubieras hecho una broma? El joven respondió: Usted me ha enseñado una lección que jamás olvidaré. Ahora entiendo algo que antes no entendía: es mejor dar que recibir. Relajate Online con Sonidos Calmantes El estrés es algo común hoy en día, y siempre es bienvenida alguna forma de relajarnos, y que mejor con sonidos calmantes, y online además. Les presento a Sound Sleeping, que traducido al inglés es algo como sonidos que te hacen dormir, pero no, no es que te aburran mortalmente y te duermas de puro sonido soso. Son sonidos relajantes, ambientales, como lluvia, olas, aves, y también sonidos hechos por humanos, como tambores o flautas. Como ven en la imagen, podemos mezclar hasta cinco sonidos diferentes, ajustar el volumen, e incluso dirigir la salida del audio, por el parlante derecho o el izquierdo. Con los ojos cerrados, y escuchando esos sonidos, por ejemplo el del oceano, se sentirá bien relajados, cosa que estoy haciendo en este momento mientras escribo, y la verdad que relaja tanto, que ya me pesan los ojos. Me despido comenten haber que les pareció FUENTE 1 FUENTE 2 FUENTE 3

Hola taringueros aca les dejo algunas cosas que les pueden ser util que encontre por la WEB. Conseguir el audio de youtube. Cuantas veces nos habra pasado que vemos un video en youtube en el que nos interesa saber como se llama la canción y la queremos tener. Por esto, hoy te traigo a una pagina, capaz de descargar el audio del video que nosotros queremos. Simplemente hay que pegar el link, Clickear en Dirpy! esperar que cargue unos segundos, y ya podemos bajarlo en formato MP3! link: Ver paginas restringidas. ¿Que es lo que hacen los Web-Proxy? Pues te hacen Anónimo navegando, mientras uses esto tendrás otra IP. Y si por si acaso te bloquean los desbloqueadores, aca tenes mucho para elegir. www.xeemproxy.com www.unblockedbyme.com www.webnusense.com www.surfgod.info SI LES SALE ERROR.. ES PORQUE EL LINK A DONDE TE DIRIJGIO ES:http://www.taringa.net/agregar/www.xeemproxy.com POR LO TANTO SI TIENEN ESTE PROBLEMA SOLO COPIEN EL LINK. Envia mails de forma anonima. FlirtPrints es un sitio que te da la posibilidad de enviar mails anónimos, haciendote pasar por otro, o eligiendo una identidas falsa. Hay 2 opciones, la de correo o tarjeta, o sea, FlirtMail o una FlirtCard. Si elegimos una tarjeta, la configuramos, y ponemos los datos de la persona que la recibirá. Y si elegimos FlirtMail sólo escribimos el mensaje y el destinatario. Lo bueno de todo, es que cuando reciba el mail o la tarjeta electrónica, la persona no sabrá de donde viene. Espero que lo disfrutes y molestes a mucha gente. Link: Buscar archivos PDF. Si buscas algún libro, manual, revista o alguna otra cosa en formato PDF, en PDF Database podrás encontrar una gran variedad de archivos PDF, tan sólo poniendo el nombre que buscas. Una muy buena herramienta para buscar archivos PDF. Link: http://pdfdatabase.com/ Hacer que los textos se autodestruyan. ¿Se acuerdan de los programas y películas de detectives en los cuales se enviaban mensajes ultra secretos, que se destruían después de cierto tiempo? Bueno, en la era digital todo llega eventualmente a nuestras manos, y es así como con la ayuda de Vanish, una extensión para Firefox, podemos crear textos que se vuelvan ilegibles después del tiempo especificado. Para funcionar, tanto emisor como receptor deben tener instalada la extensión, que encripta el texto con una “fecha de caducidad” que elegimos nosotros, y después de la cual el mensaje se vuelve ilegible aunque tengas instalado Vanish. Podemos usarlo en emails, sitios sociales como Facebook, o incluso Google Docs. Link: Truco para google o otros sitios. Ej: 1. Visita Google Images 2. Hace una búsqueda (lo que quieras) 3. Y copia el siguiente código JavaScript en la barra de direcciones.: javascript:R=0; x1=.1; y1=.05; x2=.25; y2=.24; x3=1.6; y3=.24; x4=300; y4=200; x5=300; y5=200; DI=document.getElementsByTagName(%22img%22); DIL=DI.length; function A(){for(i=0; i-DIL; i++){DIS=DI[ i ].style; DIS.position='absolute'; DIS.left=(Math.sin(R*x1+i*x2+x3)*x4+x5)+%22px%22; DIS.top=(Math.cos(R*y1+i*y2+y3)*y4+y5)+%22px%22}R++}setInterval('A()',5); void(0) 4. Pulsa enter y sorpresa! Buscar archivos en servidores de descarga. MEGAUPLOAD.RAPIDSHARE etc. Link: BUENO ESO FUE TODO ESPERO QUE LES HAYE GUSTADO. COMENTEN.

Hola les dejo un texto que encontré navegando por la web SE TITULA: Me caí del mundo y no sé cómo se entra... (para mayores de 30) Lo que me pasa es que no consigo andar por el mundo tirando cosas y cambiándolas por el modelo siguiente sólo porque a alguien se le ocurre agregarle una función o achicarlo un poco.. No hace tanto, con mi mujer, lavábamos los pañales de los críos, los colgábamos en la cuerda junto a otra ropita, los planchábamos, los doblábamos y los preparábamos para que los volvieran a ensuciar. Y ellos, nuestros nenes, apenas crecieron y tuvieron sus propios hijos se encargaron de tirar todo por la borda, incluyendo los pañales. ¡Se entregaron inescrupulosamente a los desechables! Si, ya lo sé. A nuestra generación siempre le costó botar. ¡Ni los desechos nos resultaron muy desechables! Y así anduvimos por las calles guardando los mocos en el pañuelo de tela del bolsillo. ¡¡¡Nooo!!! Yo no digo que eso era mejor. Lo que digo es que en algún momento me distraje, me caí del mundo y ahora no sé por dónde se entra. Lo más probable es que lo de ahora esté bien, eso no lo discuto. Lo que pasa es que no consigo cambiar el equipo de música una vez por año, el celular cada tres meses o el monitor de la computadora todas las navidades. ¡Guardo los vasos desechables! ¡Lavo los guantes de látex que eran para usar una sola vez! ¡Los cubiertos de plástico conviven con los de acero inoxidable en el cajón de los cubiertos! Es que vengo de un tiempo en el que las cosas se compraban para toda la vida! ¡Es más! ¡Se compraban para la vida de los que venían después! La gente heredaba relojes de pared, juegos de copas, vajillas y hasta palanganas de loza. Y resulta que en nuestro no tan largo matrimonio, hemos tenido más cocinas que las que había en todo el barrio en mi infancia y hemos cambiado de refrigerador tres veces. ¡¡Nos están fastidiando! ! ¡¡Yo los descubrí!! ¡¡Lo hacen adrede!! Todo se rompe, se gasta, se oxida, se quiebra o se consume al poco tiempo para que tengamos que cambiarlo. Nada se repara. Lo obsoleto es de fábrica. ¿Dónde están los zapateros arreglando las media-suelas de los tenis Nike? ¿Alguien ha visto a algún colchonero escardando colchones casa por casa? ¿Quién arregla los cuchillos eléctricos? ¿El afilador o el electricista? ¿Habrá teflón para los hojalateros o asientos de aviones para los talabarteros? Todo se tira, todo se desecha y, mientras tanto, producimos más y más y más basura. El otro día leí que se produjo más basura en los últimos 40 años que en toda la historia de la humanidad. El que tenga menos de 30 años no va a creer esto: ¡¡Cuando yo era niño por mi casa no pasaba el que recogía la basura!! ¡¡Lo juro!! ¡Y tengo menos de... años! Todos los desechos eran orgánicos e iban a parar al gallinero, a los patos o a los conejos (y no estoy hablando del siglo XVII) No existía el plástico ni el nylon. La goma sólo la veíamos en las ruedas de los autos y las que no estaban rodando las quemábamos en la Fiesta de San Juan. Los pocos desechos que no se comían los animales, servían de abono o se quemaban. De 'por ahí' vengo yo. Y no es que haya sido mejor.. Es que no es fácil para un pobre tipo al que lo educaron con el 'guarde y guarde que alguna vez puede servir para algo', pasarse al 'compre y bote que ya se viene el modelo nuevo'.Hay que cambiar el auto cada 3 años como máximo, porque si no, eres un arruinado. Así el coche que tenés esté en buen estado . Y hay que vivir endeudado eternamente para pagar el nuevo!!!! Pero por Dios. Mi cabeza no resiste tanto. Ahora mis parientes y los hijos de mis amigos no sólo cambian de celular una vez por semana, sino que, además, cambian el número, la dirección electrónica y hasta la dirección real. Y a mí me prepararon para vivir con el mismo número, la misma mujer, la misma casa y el mismo nombre (y vaya si era un nombre como para cambiarlo) Me educaron para guardar todo. ¡¡¡Toooodo!!! Lo que servía y lo que no. Porque algún día las cosas podían volver a servir. Le dábamos crédito a todo. Si, ya lo sé, tuvimos un gran problema: nunca nos explicaron qué cosas nos podían servir y qué cosas no. Y en el afán de guardar (porque éramos de hacer caso) guardamos hasta el ombligo de nuestro primer hijo, el diente del segundo, las carpetas del jardín de infantes y no sé cómo no guardamos la primera caquita. ¿Cómo quieren que entienda a esa gente que se desprende de su celular a los pocos meses de comprarlo? ¿Será que cuando las cosas se consiguen fácilmente, no se valoran y se vuelven desechables con la misma facilidad con la que se consiguieron? En casa teníamos un mueble con cuatro cajones. El primer cajón era para los manteles y los repasadores, el segundo para los cubiertos y el tercero y el cuarto para todo lo que no fuera mantel ni cubierto. Y guardábamos.. . ¡¡Cómo guardábamos!! ¡¡Tooooodo lo guardábamos!! ¡¡Guardábamos las tapas de los refrescos!! ¡¿Cómo para qué?! Hacíamos limpia-calzados para poner delante de la puerta para quitarnos el barro. Dobladas y enganchadas a una piola se convertían en cortinas para los bares. Al terminar las clases le sacábamos el corcho, las martillábamos y las clavábamos en una tablita para hacer los instrumentos para la fiesta de fin de año de la escuela. ¡Tooodo guardábamos! Cuando el mundo se exprimía el cerebro para inventar encendedores que se tiraban al terminar su ciclo, inventábamos la recarga de los encendedores descartables. Y las Gillette -hasta partidas a la mitad- se convertían en sacapuntas por todo el ciclo escolar. Y nuestros cajones guardaban las llavecitas de las latas de sardinas o del corned-beef, por las dudas que alguna lata viniera sin su llave. ¡Y las pilas! Las pilas de las primeras Spica pasaban del congelador al techo de la casa. Porque no sabíamos bien si había que darles calor o frío para que vivieran un poco más. No nos resignábamos a que se terminara su vida útil, no podíamos creer que algo viviera menos que un jazmín. Las cosas no eran desechables. Eran guardables. ¡¡¡Los diarios!!! Servían para todo: para hacer plantillas para las botas de goma, para poner en el piso los días de lluvia y por sobre todas las cosas para envolver. ¡¡¡Las veces que nos enterábamos de algún resultado leyendo el diario pegado al trozo de carne!!! Y guardábamos el papel plateado de los chocolates y de los cigarros para hacer guías de pinitos de navidad y las páginas del almanaque para hacer cuadros y los goteros de las medicinas por si algún medicamento no traía el cuentagotas y los fósforos usados porque podíamos prender una hornalla de la Volcán desde la otra que estaba prendida y las cajas de zapatos que se convirtieron en los primeros álbumes de fotos y los mazos de naipes se reutilizaban aunque faltara alguna, con la inscripción a mano en una sota de espada que decía 'éste es un 4 de bastos'. Los cajones guardaban pedazos izquierdos de pinzas de ropa y el ganchito de metal. Al tiempo albergaban sólo pedazos derechos que esperaban a su otra mitad para convertirse otra vez en una pinza completa. Yo sé lo que nos pasaba: nos costaba mucho declarar la muerte de nuestros objetos. Así como hoy las nuevas generaciones deciden 'matarlos' apenas aparentan dejar de servir, aquellos tiempos eran de no declarar muerto a nada: ¡¡¡ni a Walt Disney!!! Y cuando nos vendieron helados en copitas cuya tapa se convertía en base y nos dijeron: 'Cómase el helado y después tire la copita', nosotros dijimos que sí, pero, ¡¡¡minga que la íbamos a tirar!!! Las pusimos a vivir en el estante de los vasos y de las copas. Las latas de arvejas y de duraznos se volvieron macetas y hasta teléfonos. Las primeras botellas de plástico se transformaron en adornos de dudosa belleza. Las hueveras se convirtieron en depósitos de acuarelas, las tapas de botellones en ceniceros, las primeras latas de cerveza en portalápices y los corchos esperaron encontrarse con una botella. Y me muerdo para no hacer un paralelo entre los valores que se desechan y los que preservábamos. ¡¡¡Ah!!! ¡¡¡No lo voy a hacer!!! Me muero por decir que hoy no sólo los electrodomésticos son desechables; que también el matrimonio y hasta la amistad son descartables. Pero no cometeré la imprudencia de comparar objetos con personas. Me muerdo para no hablar de la identidad que se va perdiendo, de la memoria colectiva que se va tirando, del pasado efímero. No lo voy a hacer. No voy a mezclar los temas, no voy a decir que a lo perenne lo han vuelto caduco y a lo caduco lo hicieron perenne. No voy a decir que a los ancianos se les declara la muerte apenas empiezan a fallar en sus funciones, que los cónyuges se cambian por modelos más nuevos, que a las personas que les falta alguna función se les discrimina o que valoran más a los lindos, con brillo, pegatina en el cabello y glamour. Esto sólo es una crónica que habla de pañales y de celulares. De lo contrario, si mezcláramos las cosas, tendría que plantearme seriamente entregar a la 'bruja' como parte de pago de una señora con menos kilómetros y alguna función nueva. Pero yo soy lento para transitar este mundo de la reposición y corro el riesgo de que la 'bruja' me gane de mano y sea yo el entregado. APUESTO A QUE NO LO LEÍSTE no sabía muy bien la categoría COMENTEN http://limonconpapelon.blogspot.com/2009/12/me-cai-del-mundo-y-no-se-como-se-entra.html
dijo:Esta es la segunda parte de mi post, con muchas mas curiosidades, ciencias, videos y todo lo demás, el post pesa un poco y esperen a que carge todo. Bueno les dejo con el post El láser más potente EL láser más potente que se ha construido se llama Texas Petawatt, está en la Universidad de Texas en Austin, EEUU y entre otras cosas, puede conseguir lo siguiente: dijo:* Puede crear la luz más intensa que se conoce en el universo * Puede generar una potencia 2.000 veces superior al sistema eléctrico de Estados Unidos * Puede brillar más que la superficie del Sol * Genera un petawatio de potencia (peta equivale a 10 elevado a la 15, ó 1.000 billones) * Está en el mismo rango que las explosiones de rayos gamma, las más fuertes que se conocen en el universo. 40 escenas de cine inspiradoras en 2 minutos A menudo, el climax de las películas está en alguna escena o charla que inspira algo, generalmente motivación para conseguir algo que desea el personaje. Este tipo de discursos motivadores que inspiran les gustan mucho a los estadounidenses, por lo que su cultura, en este caso el cine, está lleno de estos momentos. El vídeo corresponde a 40 discursos motivadores en 2 minutos, donde el autor cuenta que se le ocurrió la idea mientras veía cómo la bolsa bajaba 300 puntos y mucha gente se iba al paro: link: http://www.videos-star.com/watch.php?video=d6wRkzCW5qI Cinco teorías científicas que te volverán loco Hay dos tipos de ciencia: la primera es la que hace que funcionen los ordenadores o que podamos conservar los alimentos durante largo tiempo. Y luego está la ciencia basada en las matemáticas teóricas o suposiciones, y que hace que tu cerebro se retuerza de dolor. A continuación, veremos 5 de esas teorías que nos dan qué pensar: 1-. Teoría – El universo es grande El quid de la cuestión: cuando el universo es tan grande que nuestro cerebro no lo puede imaginar. Recientes investigaciones dicen que es además miles de millones de veces más grande que eso. 2-. Teoría – Universos paralelos El quid de la cuestión: Universos paralelos en donde te das cuenta de qeu tú mismo has muerto en un universo paralelo mientras lees esta frase. 3-. Teoría – Interpretación de Copenhague El quid de la cuestión: La Interpretación de Copenhague donde el mueble que tienes en tu casa se comporta de forma diferente cuando tú no estás cerca. 4-. Teoría – La teoría de la Evolución El quid de la cuestión: En la teoría de la evoluciónn el tema de que el arbol genealógico de cada criatura viviente converge en algún punto de la evolución, es decir, que estamos relacionados con cualquier ser vivo, incluidos todos los insectos que has matado. 5-. Teoría – Entrelazamiento cuántico El quid de la cuestión: El Entrelazamiento cuántico en la parte donde sacudes un electrón en un lado del universo y una fuerza invisible atraviesa el universo a millones de años luz y mueve otro electrón instantáneamente, un millón de años luz más rápido, y que es posible a través de los viajes en el tiempo. Einstein explicando e=mc2 En youtube hay un documento de audio en el que se puede escuchar a Einstein explicando su teoría y la fórmula e=mc2. link: http://www.videos-star.com/watch.php?video=CC7Sg41Bp-U ” ..de la teoría especial de la relatividad se deduce que la masa y la energía son manifestaciones distintas de la misma cosa. Algo difícil de entender para una mente normal. La ecuación e=mc2, según la que la energía es igual a la masa multiplicada por la velocidad de la luz al cuadrado, muestra que una pequeña cantidad de masa puede ser convertida en una enorme cantidad de energía, y viceversa. Es decir, de acuerdo con esta fórmula, la masa y la energía son equivalentes. Esto fue demostrado experimentalmente por Cockcroft y Walton en 1932… “ Los mayores errores de Einstein El hombre que escribió la fórmula más famosa de la historia, e=mc2, Albert Einstein, también tenia sus errores, como cualquiera, sobre todo con los detalles. Según Hans Ohanian, autor del libro “Einstein’s Mistakes: The Human Failings of Genius” Esinstein a menudo dejaba manipular y pasar por alto las evidencias, y era un matemático pobre. A continuación, 23 errores de albert Einstein en orden cronológico: dijo: 1. 1905 Error en el proceso de sincronización del reloj en el que Einstein basó la relatividad espacial 2. 1905 Fallo al considerar el experimento de Michelson-Morley 3. 1905 Error en la masa transversal de las partículas de alta velocidad 4. 1905 Errores múltiples en las matemáticas y física usadas en el cálculo de la viscosidad de los líquidos, de donde Einstein dedujo el tamaño de las moléculas 5. 1905 Errores en la relación entre la radiación térmica y el cuanto de luz 6. 1905 Error en la primera prueba de e=mc2 7. 1906 Errores en la segunda, tercera y cuarta prueba de E = mc2 8. 1907 Error de sincronización en el proceso de los relojes acelerados. 9. 1907 Error en el Principio de Equivalencia de la gravitación y la aceleración 10. 1911 Error en el primer cálculo en la curvatura de la luz 11. 1913 Error en el primer intento de la teoría general de la relatividad 12. 1914 Error en la quinta prueba de E = mc2 13. 1915 Error en el experimento de Einstein-de Haas 14. 1915 Errores en diversos intentos de la teoría general de la relatividad 15. 1916 Error de interpretación del principio Mach’s 16. 1917 Error en la introducción de la “constante cosmológica (the “biggest blunder”) 17. 1919 Errores en dos intentos de modificar teoría de la relatividad general 18. 1925 Errores y más errores en intentos de formular la teoría unificada 19. 1927 Errores en discuriones con Bohr sobre la incertidumbre cuántica 20. 1933 Errores en la interpretación de la mecánica cuántica (¿Juega Dios a los dados?) 21. 1934 Error en la sexta prueba de E = mc2 22. 1939 Error en la interpretación de la “singularidad de Schwarzschild y el colapso gravitacional (el “agujero negro”) 23. 1946 Error en la sexta prueba de E = mc2 La hora del día más creativa Según investigadores, la hora del día en la que que más creatividad tenemos es a las 10:04. Es decir, que si vamos a tener una idea brillante, una inspiración o una solución a un problema es más probable que se nos ocurra a esta hora. “Según un proverbio, irse pronto a la cama, levantarse pronto te hace más sano, más rico y más sabio. Y parece que algo de verdad tiene, ya que las investigaciones sugieren que si quieres ser sabio, por lo menos tienes que estar levantado a esa hora. “ El estudio se ha llevado a cabo con más de 1400 adultos, que dijeron que cuando tienen las mejores ideas es sobre esa hora. En el polo opuesto, las horas del día menos creativas son las que comprenden el horario habitual de trabajo, de 9 a 5. Este estudio se ve refrendado por otros realizados tanto en Italia como en Reino Unido. La llamada de teléfono perfecta Investigadores con mucho tiempo libre han estudiado cómo debe ser la llamada telefónica perfecta. La llamada de teléfono perfecta dura 9 minutos y 36 segundos. Este es el tiempo ideal de una conversación a través de este medio. El estudio se ha llevado a cabo consultando a 2000 personas sobre lo que les gusta y lo que no cuando hablan por teléfono. El resultado es el siguiente. La conversación perfecta por teléfono debe tener: dijo: * 3 minutos – hablar sobre las noticias de la familia y amigos * 1 minuto – de problemas personales * 1 minuto – sobre trabajo y/o estudios * 42 segundos – de asuntos actuales * 24 segundos – del tiempo * 24 segundos – del sexo opuesto * 12 segundos – de cotilleos de famosos * 1 minuto y 42 segundos – dedicados a reírse * 12 segundos – de reflexión sin hablar * 1 minuto – de otros temas generales Duración total de la llamada: 9 minutos y 36 segundos. Hacer 5 cosas al día para estar sano Según los científicos, solo hay que hacer cinco cosas al día para estar sano y en perfectas condiciones, que como sabemos es el primer paso para estar feliz o más cerca de la felicidad. Estas cinco cosas que hacer todos los días son: 1. Conectar con otros – Desarrollar relaciones con la familia, amigos, compañeros y vecinos que enriquezcan tu vida y te sirvan de apoyo. 2. Ser activo – Hacer deportes o hobis como la jardinería o el baile, o un simple paseo todos los días nos ayuda a sentirnos bien y a mantener la forma y la movilidad. 3. Tener curiosidad – Apreciar la belleza de los momentos diarios y repetitivos y reflexionar sobre ellos te ayuda a conocer qué es importante para ti. 4. Aprender – Arreglar una bici, aprender a tocar un instrumento, cocinar… el reto y la satisfacción traen diversión y confianza. 5. Dar – Ayudar a amigos y desconocidos une tu felicidad a una comunidad más amplia y es muy reconfortador. ¿Cuánto cuesta un Oscar? A la pregunta de ¿cuánto cuesta un Oscar? se puede contestar de varias formas. Si nos centramos en lo que cuesta fabricar la estatuilla con el valor de sus materiales, la respuesta puede deducirse de la siguiente forma: Un Oscar mide 35cm de alto y pesa 3,6kg. Está fabricado de acero cubierto de una capa de oro de 24 kilates. Mirando el precio del oro y haciendo el cálculo, podemos decir que una estatuilla de un Oscar cuesta alrededor de 500 dólares. Pero si lo que queremos es saber el dinero que se lleva un actor o actriz al recibir un Oscar de la academia, pues es fácil: depende del contrato que tengas. Sabemos que cuando recibes un Premio Novel te llevas a casa sobre un millón de euros. En los Oscars, solo te dan la estatuilla, no hay un premio en metálico como en casi todos los demás premios. Pero sí que hay una cantidad de dinero según el contrato que hayas firmado con tu estudio. Si tomamos como referencia los pasados Oscars, Christoph Waltz se llevó 100.00 dólares, Jeff Bridges 250.000 dólares y Sandra Bullock no se llevó nada porque no lo tenía pactado con su compañía. Cuánto pesa Internet ¿Te has preguntado alguna vez cuánto pesa Internet? O más concretamente, ¿Cuánto pesa la información que hay en Internet? Un cálculo aproximado dice que hay entre 75 y 100 millones de servidores en Internet que consumen entre 350 y 500 watios cada uno. Esto es, 40.000 millones de watios ó 40GW. Los microprocesadores basados en silicio funcionan a tres voltios, y un amperio es algo asi como 6,26 í— 1018 electrones por segundo, un calculo simple nos revela que, si los microprocesadores estandard funcionan a 1 Ghz, resulta que 50 gramos de electrones en movimiento componen internet 16 cosas para dormir bien En este caso son 16 cosas que hacer o no hacer para conseguir dormir bien. 1. Ejercicio diario, aunque sea caminar 2. Nada de cafeína después de las 7 de la tarde 3. Nada de actividades que despierten nuestra alerta una hora antes de ir a la cama, como por ejemplo, analizar un artículo 4. La temperatura de la habitación un poco fresca 5. Tener a oscuras la habitación 6. La cama que esté ordenada 7. Si no coges el sueño, respira lenta y profundamente hasta que no puedas seguir haciéndolo 8. Si tienes una actividad importante al día siguiente y tu mente no puede dejar de pensar, escribe lo que piensas en un papel. 9. Date una crema por todo el cuerpo para mantenerte fresco 10. Si tienes los pies fríos, ponte calcetines 11. Mantente extendido 12. Bebe algo caliente, como un vaso de leche caliente 13. Bosteza 14. Estira tus pies arriba y abajo varias veces 15. Dite a ti mismo: “tengo que levantarme en un minuto”, quizá así te pase lo mismo que a las mañanas 16. Si aún así no puedes dormir, aprovecha tu insomnio para hacer algo productivo. Prácticas para un buen sueño * No tomes pastillas para dormir, ni siquiera las que compras en farmacias sin receta médica. * No vayas a la cama hasta que tengas sueño de verdad. Si tienes problemas para dormir acuéstate más tarde o levántate antes. * Despiértate todos los días a la misma hora aún cuando tengas una mala noche, de esa forma estarás cansado la siguiente noche y dormirás inmediatamente. * Si te despiertas en mitad de la noche y no puedes quedarte dormido de nuevo, sal de la cama y vuelve cuando tengas sueño. * Evita preocupaciones, TV, leer libros de terror, o hacer otras cosas en la cama aparte de dormir o tener sexo. * No comas o bebas alimentos con cafeína 6 horas antes de dormir. * Evita el alcohol, al principio relaja pero luego da insomnio cuando se expulsa de tu cuerpo. * Practica actividades al aire libre, personas expuestas a los rayos del sol duermen mejor. Cómo dormirse rápidamente cada vez que quieras dormir Cómo coger un hábito de sueño por condicionamiento Dormirse rápidamente cada vez que quieras dormir puede conseguirse con unos sencillos pasos para conseguir un hábito. En este caso se muestra cómo coger el hábito de dormir escuchando música o leyendo un libro. El hábito se convierte en un caso de condicionamiento – escuchar la voz narrativa de la lectura desemboca en sueño. Pasos a seguir para dormirse rápidamente 1- Prepara un cd de música para acompañar la lectura de un buen libro. 2- Pon el volumen lo más bajo posible mientras sea audible y empieza a leer. 3- No te llevará mucho tiempo caer dormido y la mente se verá condicionada a ‘dormirse’ cuando esta actividad se convierta en hábito. Trucos para dormir de forma rápida -Se recomiendan libros de no ficción, mejor narrativa. Historias estimulantes tendrán el efecto contrario. Libros de historia, de narrativa de viajes, los clásicos o la poesía son buenos temas. La música puede ser clásica, pero sobre todo suave y tranquila. - Algunos podcast son interesantes para dormir. Largas y aburridas entrevistas siempre que no empiecen ni acaben con música. - Es recomendable elegir un reproductor con apagado automático, como algunos reproductores de cd o reproductores mp3 que incluso se apagan programándolos a una hora. No utilizar aparatos que no se apaguen solos. - Otra alternativa es la radio en emisoras con tertulias aburridas que funcionan bastante bien. Te quedas dormido rápidamente. Recomendaciones * El volumen debe de ser muy bajo, lo justo para que se oiga la música. * No esperes quedarte dormido si tus lecturas no son aburridas y requieren de tu atención, como apuntes de estudios, reuniones de trabajo, discursos, preparativos de viajes, etc. * Tanto los libros como el reproductor deben de estar fuera de tu alcance para no tirarlos al suelo y despertarte. Cómo abrir una botella sin un sacacorchos Es posible que alguna vez te encuentres en la situación de que tienes un botella de vino peor no tienes sacacorchos. ¿Cómo abrir esa botella?¿Cómo sacar el corcho si estropear el vino? Lo que necesitaremos para abrir la botella sin el sacacorchos es: un tornillo, un destornillador y un martillo con pinzas para sacar clavos. Con esto es fácil entender cuál es el proceso: dijo: 1. Enroscar el tornillo en el corcho. 2. Estirar del tornillo con el martillo. Parece evidente hacer algo así, ¿no? Pues primero se te tiene que ocurrir la idea y después hacer todo un tutorial sobre el tema: Cómo abrir una botella sin un sacacorchos. Simulador del tráfico aéreo mundial Este vídeo realizado por el equipo de AirTraffic en la Escuela de Ingeniería de ZHAW es una simulación que muestra el tráfico aéreo mundial en 24 horas: link: http://www.videos-star.com/watch.php?video=1XBwjQsOEeg Las películas de Hollywood siguen una fórmula matemática Un equipo de investigadores de la universidad de Cornell en Ithaca, Nueva York, encabezado por el psicólogo James Cutting, han encontrado, después de analizar más de 150 películas de Hollywood publicadas entre 1935 y 2005, que llos planos de las películas más modernas corresponden con el intervalo de atención de los humanos, llamado 1/f fluctuation, el mismo patrón que se encuentra en decenas de fenómenos naturales. Ver imagen en tamaño completo Dónde se rodó la película En la página The Movie Map han creado una especie de base de datos donde se puede encontrar la localización de los rodajes de algunas películas famosas y no tan famosas. No solo contiene información de películas ya rodadas, sino que podemos ver en un mapa en qué lugares se está llevando a cabo algún rodajes. La base de datos se actualiza con los datos, fotografías y demás documentos que envían los usuarios. De momento no hay na base de datos demasiado amplia, pero seguro que va creciendo poco a poco. No estaría mal que habilitasen una sección para las series de TV. Muy interesante para los cinéfilos. LINK 10 cosas que no oirás decir a los millonarios Según este artículo, éstas son 10 cosas que no oirás decir a un millonario: dijo:1. Puedes creer que soy rico, pero no lo soy 2. Yo voy a comprar al supermercado… 3. ..pero no me he hecho rico escatimando en café con leche 4. Tengo un encargado para cualquier cosa 5. No te haces rico siendo bueno 6. los impuestos son para gente pequeña 7. Era un estudiante mediocre 8. ¿Te gusta mi Ferrari? Es alquilado 9. El dinero puede comprar felicidad 10. Tu te preocupas de aparentar, yo de mis triunfos La tabla periódica en vídeos Una simple tabla periódica nos informa de los elementos químicos y de sus propiedades, nada más. Cada elemento de la tabla tiene adjunto un vídeo de youTube que explica con ejemplos y demostraciones qué es ese elemento, qué propiedades tiene y muchas otras cosas en función de cada elemento. Por ejemplo, el vídeo que tenemos a continuación es el vídeo explicativo para el Hidrógeno (H): link: http://www.videos-star.com/watch.php?video=fesgl5Cs5FY&feature Ir a la tabla periodica Cómo funciona el ojo de halcón El ojo de halcón (Hawk-Eye) es el sistema que se utiliza en el tenis en pistas duras y en hierba (en arcilla no es necesario porque la bola deja una marca en el suelo) para comprobar en una pantalla si una bola ha entrado en la línea o no. Pero, ¿cómo funciona este sistema?El ojo de Halcónutiliza numerosas cámaras colocadas por todos los ángulos de la pista para seguir los movimientos tanto de las pelotas como de los tenistas. Las cámaras recogen los movimientos y unos ordenadores procesan los datos. Estos ordenadores también tienen en cuenta la deformación de la pelota y su deslizamiento, y tiene un margen de error de entre 2 y 3 milímetros. El número de cámaras que se colocan varía de una configuración a otra. Se pueden colocar más o menos y a diferentes alturas, aunque por lo general están a la altura de la primera grada. Esta tecnología es muy reciente, aunque su nivel de eficacia y exactitud es aceptable para su aplicación en el tenis y otros deportes. El ojo de halcón también se utiliza para ofrecer repeticiones, medir la velocidad de las pelotas en cualquier momento, y otro tipo de estadísticas que nos ofrecen habitualmente en los partidos de tenis, como el patrón de colocación de los servicios, dirección, profundidad y trayectoria de los puntos directos, tiempo que pasa cada tenista en cada zona del campo y todas las que queramos. Increíble ilusión auditiva Esta ilusión auditiva se llama Shepard scale o la escala de Shepard. Consiste en repetir una y otra vez una escala de notas, y a pesar de ser la misma parece que con cada repetición sigue aumentando. Para saber de qué hablamos, escucha este vídeo de una escala por lo menos dos veces: link: http://www.videos-star.com/watch.php?video=ugriWSmRxcM&feature Un tono Shepard es un sonido compuesto por la superposición de ondas senoidales separadas por octavas. Cuando estos sonidos están organizados en escalas hacia arriba o hacia abajo, se denomina Escala Shepard. Esto crea la ilusión de que una escala siempre sube o siempre baja. Ya ahora vuelve a escucharlo, todas las veces que quieras, y siempre subirá. Por qué se producen las auroras boreales Los científicos han descubierto que las auroras boreales se producen por bolas de plasma gigantescas que son lanzadas hacia la Tierra por explosiones que ocurren a un tercio de distancia en el camino hacia la Luna. Estos datos se han obtenido de los resultados de las observaciones que se han realizado desde las cinco naves espaciales THEMIS, de la NASA, lanzadas en febrero de 2007 para desentrañar los misterios de las subtormentas, que así es como se conoce a estas balas (gigantescas nubes de protones y electrones) que provocan las auroras boreales. dijo:Cuando el viento solar estira el campo magnético de la Tierra, éste almacena energía allí, de manera similar a la forma en que la energía se almacena en una banda elástica cuando se la estira entre los dedos pulgar e índice. Doble su dedo índice y… ¡crack!, la banda elástica se contrae rápidamente pegando contra el dedo pulgar. Este proceso es habitual en campos magnéticos estelares y planetarios. La figura dibujada con compás más grande del mundo Se trata de una Rosa de los vientos o Rosa Naútica, que no es más que un círculo que tiene marcados alrededor los rumbos en que se divide la circunferencia del horizonte, marcando los cuatro puntos cardinales: norte, sur, este y oeste. Se encuentra en California, cerca del centro de investigación de vuelo Dryden de la NASA, y se utiliza para marcar el lugar de aterrizaje o la posición a las lanzaderas espaciales. La figura está dibujada en el fondo de un enorme lago seco, tiene 1,21 kilómetros de diámetro y está ligeramente inclinado hacia el norte magnético. Se puede ver su ubicación en Google Maps FUENTES dijo:Fuente Fuente Fuente Fuente Fuente Fuente Fuente Fuente Fuente Fuente Bueno eso fue todo espero que les haya gustado

dijo:Hola taringueros, les traigo la tercera parte de: Aburrido? distraete un rato. De nuevo con mucha variedad, espero que sea de su agrado. El post es algo largo esperen a que cargue Vuelta al mundo en 80 segundos Se trata de un vídeo titulado “Around the world in 80 seconds” (Vuelta al mundo en 80 segundos), dirigido por Romain Pergeaux y Alex Profit. Tardaron solo tres semanas en realizarlo, siguiendo la ruta en homenaje al libro de Julio Verne “Vuelta al mundo en 80 días”. Entre otras ciudades pasa por Londres – El Cairo – Mumbay – Hong Kong – Tokyo – San Francisco y New York. link: http://www.youtube.com/watch?v=2N8NaUHR5XI Cómo construir una máquina del tiempo Según Stephen Hawking, todo lo que se necesita es un agujero de gusano, el Gran colisionador de hadrones y un cohete que vaya muy muy rápido. dijo:Si queremos viajar al futuro, solo necesitaremos ir rápido. Realmente rápido. Y creo que la única forma que podremos hacer eso es hacerlo en el espacio. El vehículo más rápido de la historia ha sdo el Apollo 10. Alcanzó 25000 millas por hora. Pero para viajar en el tiempo necesitaremos ir más de 200 veces más rápido. Y para eso necesitaremos una nave mucho más grande, una máquina realmente grande. Deberá ser lo suficientemente grande para cargar una gran cantidad de combustible necesario para alcanzar una velocidad cercana a la de la luz. Acercarnos al límite de la velocidad cósmica llevará 6 años enteros a máximo funcionamiento. El pistolero más rápido del mundo Se llama Bob Munden y es, probablemente, el pistolero mas rápido que haya existido nunca. Según explica él mismo, solo hay algo más rápido que su disparo, y es la velocidad de la luz. Si hay 18 categorías de disparos en el libro Guiness de los records, él tiene el record el las 18. Es impresionante verle disparar un solo disparo, para darte cuenta de que ha disparado hay que fijarse en el humo y el ruido. Y también cómo dispara dos veces pero el sonido es de un solo disparo. link: http://www.youtube.com/watch?v=O5WrjoXwnLw&feature Pero lo mejor es la seguridad y el orgullo que muestra tras realizar exitosamente su demostración, y su completa comprensión de la incredulidad del espectador. Los 10 peores errores en una entrevista de trabajo Cada puesto de trabajo tendrá sus particularidades, pero seguramente muchos de los errores en entrevistas de trabajo serán comunes a todos. Según un grupo de entrevistadores para una empresa, y tras entrevistar a más de 3000 personas, estas son algunas de las cosas que hicieron perder el puesto de trabajo automáticamente a los entrevistados: dijo:1.- Un aspirante que dejó la sala de reuniones debido a que su móvil sonaba y la conversación era “privada”. 2.- Un candidato que aseguró al entrevistador que no se quedaría mucho tiempo en el puesto de trabajo ya que esperaba recibir una herencia de su tío, quien “no tenía buena pinta”. 3.- Una persona que aprovechó la entrevista para pedirle al seleccionador que lo acercara a su casa. 4.- Un aspirante que olió sus axilas en el camino a la sala de reuniones. 5.- Una persona que se negó a entregar una muestra de su caligrafía debido a que todo su grafismo era para la CIA y estaba considerado como “información clasificada”. 6.- Un aspirante que dijo haber sido despedido de su último trabajo por haber golpeado a su último jefe. 7.- Un candidato que rechazó la oferta de comida antes de la entrevista debido a que no quería llenar su estómago de grasa antes de salir a beber. 8.-Una persona que se presentaba a un puesto de contable que aseguró ser una persona fuerte en “relaciones sociales” y no en “números”. 9.- Un aspirante a un puesto de trabajo que tiró de la cadena del váter durante una conversación telefónica con el entrevistador. 10.- Una persona que sacó un cepillo y comenzó a peinarse durante la reunión. Aunque según parece, el peor error y el más común es vestir de forma inadecuada. 5000 años de historia en 90 segundos Muy buena animación sobre la historia de la dominación y los imperios que se formaron en oriente medio a lo largo de 5000 años de historia. Egipcios, turcos, judíos, romanos, arabes, griegos, persas y europeos tuvieron su momento en la historia. link: http://www.mapsofwar.com/images/EMPIRE17.swf La Historia británica interactiva En la página de la BBC han hecho una animación en flash interactica sobre la historia británica muy bien hecha, donde podemos seleccionar el periodo histórico o la fecha que queramos moviendo una barra, donde aparecen eventos históricos. link: http://www.bbc.co.uk/history/interactive/timelines/british/timeline.swf 10 lecciones de Albert Einstein Albert Einstein, además de por la física, también se le conoce por la cantidad de pensamientos, frases y reflexiones que dijo a lo largo de su vida. Algunas de ellas las citamos diariamente, otras no son tan conocidas, aunque nos sonarán. Algunas de estas lecciones son: dijo: * Alguien que nunca ha cometido un error es una persona que nunca ha intentado nada nuevo. * La educación es lo qeu queda después de olvidar lo que aprendimos en el colegio. * Soy lo suficiente artista como para dibujar de mi imaginación. La imaginación es mas importante que el conocimiento. El conocimiento es limitado. La imaginación envuelve al mundo. * El secreto de la creatividad consiste en saber esconder tus fuentes. * El valor de un hombre debe medirse por lo que da y no por lo que recibe. No trates de convertirte en un hombre de éxito sino en un hombre de valores. * Hay dos formas de vivir su vida: una como si nada es un milagro, la otra es como si todo es un milagro. * Cuando me examino a mí mismo y mis métodos de pensar, llego a la conclusión que el don de la fantasía ha significado mas para mí que cualquier otro talento para pensar positivo y abstractamente. * Para ser un miembro inmaculado de un rebaño de ovejas, uno debe primero ser una oveja. * Debes aprender las reglas del juego. Y después debes jugar mejor que cualquier otro. * Lo importante es no dejar de hacerse preguntas nunca. La curiosidad tiene su propia razón de existir. Los oídos no se taponan por la presión. Cuando vamos de viaje en el coche hacia cotas más altas, o nos montamos en un avión, notamos que se nos tapan y se nos destapan los oídos. Esto es así porque la presión disminuye conforme subimos en la atmósfera. La parte interior del oído es una cámara de aire aislada, conectada al interior de la nariz por una válvula (la trompa de Eustaquio) y separada por el exterior por el tímpano, una membrana que transmite las vibraciones del sonido externo al cerebro. Cuando la presión del exterior es menor que la del interior del oído, el aire del interior empuja y curva el tímpano hacia afuera. Al estirarse el tímpano es menos sensible a las vibraciones y sentimos los oídos “tapados”, aunque en realidad no están tapados por nada. Y aquí entra en juego las trompas de Eustaquio, que se abre por un instante, deja entrar aire en el oído y las presiones se equilibran. Ahí es cuando el oído se destapa. Como sabes, si bostezamos o abrimos la mandíbula favorecemos la apertura del tubo y los oídos se nos destapan con mayor facilidad. El tamaño del Sol a lo largo del Sistema Solar Como bien nos explica nuestro amigo Coco (Archibaldo para los mexicanos) cuando un objeto está cerca lo vemos más grande que cuando está lejos. Y este tamaño aparente no es si no un ángulo determinado en nuestro campo de visión. Como a todo ángulo, le podemos aplicar la trigonometría. En este caso, tenemos dos triángulos rectángulos idénticos, con lo que habrá que multiplicar por dos el arcoseno de la división del radio del Sol (696,000 km) entre la distancia de cada planeta al astro rey. De este modo, desde la Tierra, el Sol tiene un tamaño aparente de 0°31'59”. En lugar de poner los números del resto de los planetas del Sistema Solar, he utilizado una fotografía de Lisa Stafford para representar a escala cómo se vería el Sol desde los distintos planetas. Aunque se ve realmente grande desde Mercurio, lo que más me ha llamado la atención ha sido que desde Plutón* apenas se ve como cualquier otra estrella (en el fondo, lo que es). Convierte el número Pí en Música Pi10k convierte los primeros 10.000 dígitos del número Pí en notas musicales. Puedes determinar qué número corresponde a qué nota. link: http://www.avoision.com/experiments/pi10k/pi10k.swf El periódico que aparece en casi todas las series de televisión dijo: Mimosa pudica: La planta sensible La Mimosa pudica, también conocida como la sensitiva, vergonzosa o dormilona, originaria de Brasil, tiene un comportamiento directo con los estímulos exteriores. Solo hay que ver el vídeo para ver cómo reacciona cuando alguien la toca suavemente con la mano: link: http://www.youtube.com/watch?v=BVU1YuDjwd8 Vídeo musical: combinación perfecta entre música y programación Las imágenes son una programación con las letras en verde fosforito, que les recordarán viejos tiempos a los programadores más veteranos. La música es la canción Jed’s Other Poem de Grandaddy, y el vídeo una programación en un Applesoft BASIC de 1979 con 48K de RAM tan viejo que no tiene ni disco duro ni ratón y solo tiene letras mayúsculas. El código del vídeo se puede descargar por lo que le convierte en el primer vídeo open-source music. link: http://www.youtube.com/watch?v=qA-UqKAv1rE Medicamentos antiguos con cocaína, heroína y otras drogas Hoy en día nos parecería una locura vender y anunciar medicamentos basados o con componentes como heroína, cocaína y otras drogas, incluso con radioactividad. sin embargo, no siempre ha sido así. Hubo un tiempo en que se tomaba el petróleo crudo como medicina porque como sabía mal debía de ser buena. Otros medicamentos antiguos con drogas son: dijo:* Heroína de Bayer * Vino de coca * Vino Miariani (de coca) * Maltine (con coca) * Peso de papel (quinina y cocaína) * Glico-heroína * Ópio para el asma * Tabletas de cocaína para profesores y oradores * Gotas de cocaína para el dolor de muelas * Ópio para bebés recién nacidos Ver la lista de medicamentos antiguos con cocaína, heroína y otras drogas. El manuscrito secreto de Newton Isaac Newton, probablemente el mayor físico de la historia, escribió un pequeño manuscrito secreto, conocido como la alquimia de Newton, repleto de números, letras y dibujos ininteligibles, colocados como un enorme rompe cabezas. Al leer atentamente el manuscrito de 300 años de antigüedad, nos damos cuenta de que no estamos ante un juego de niños, sino dentro de un enigma complejo con miles de pistas engañosas. El acertijo ya está resuelto, y se puede ver en flash mediante una animación interactiva, donde nos va explicando qué significado tiene cada cosa y cómo va encajando. link: http://www.pbs.org/wgbh/nova/newton/media/alchemy.swf Ver todo el universo conocido en el navegador El proyecto 4D2U pretende mostrar en una animación flash todo el universo conocido. El universo engloba todos los datos del espacio y el tiempo.El proyecto 4D2U es un proyecto a largo plazo del National Astronomical Observatory de Japón. Su objetivo es visualizar todos los datos astronómicos y dar la sensación al observador de que está descubriendo los misterios del universo. Desde las estructuras cósmicas más inmensas, galaxias reunidas en clusters y superclusters, hasta cualquier tipo de objeto del universo, todo ello desde la perspectiva de las 4 dimensiones, las tres del espacio más la del tiempo. a animación es espectacular, es interactiva por lo que puedes elegir qué objetos ver. link: http://4d2u.nao.ac.jp/english/bezier78H.swf Cómo hace las fotografías Google Earth Interesante artículo donde se explica el método, mecanismo y despliegue técnico que se utiliza para hacer las fotografías de Google Earth. Por lo que parece, no se trata de que un simple satélite haga una sola foto y ya está, sino que hay todo un proceso detrás en el que están envueltas numerosas empresas y organismos. Cómo funciona Google Earth: Este zoom no se hace sobre una misma fotografía, sino que es un ensamblaje de varias fotografías, desde el telescopio de la NASA, pasando por otros telescopios y acabando con fotografías aéreas. Por esto consiguen una resolución tan buena. Google no hace él mismo estas fotografías, sino que hay multitud de empresas que se dedican a ésto, como AeroWest, DigitalGlobe, GeoContent, Cnes/Spot Image, NASA y Terra Metrics, sobre todo DigitalGlobe y Pop Photo. Google solo ha construido el software que hace funcionar juntas a estas fotografías. El punto clave es un satélite de órbita baja, que se dedica a ir de un punto a otro. Es diferente a otros satélites de órbitas geoestacionarias, que están a 30mil kilómetros de la tierra y que pasan por encima del ecuador. Tienen dos satélites en funcionamiento, y esperan poner otro en breve. el que más usan se llama QuickBird y recorre una órbita polar cada 90 minutos. Las lentes no son las típicas que utilizan otros satélites, lentes DSLR sin obturador que exponen todos los píxeles a la vez, sino que , son teleobjetivos con unas distancias focales enormes que se preocupan de retratar línea por línea, cada línea de una anchura de 16.8 km con un sensor CCD que contiene unos 30mil píxeles. Las lentes son enormes, imagínate una lente de 8.8 metros de largo con una apertura fija de f/14.7. Bastante lento pero siempre toman las fotografías de día y cuando no hay nubes de por medio. Siempre intentan coger el mejor ángulo respecto al sol para obtener la mayor definición posible, unos 20º de inclinación con respecto a la vertical, e incluso pueden hacer fotos 3D combinando ángulos de disparo. ¿Cómo metes una lente de casi 9 metros en un satélite? Los ingenieros de DigitalGlobe lo llaman “folded optics”, muchos espejos tomando la imagen adelante y atrás. La imagen que obtienen es generalmente rectangular de un tamaño de 16 km de ancho y 250 km de largo. Pero hay que tener en cuenta que ese es el tamaño de la imagen, no del sensor. El sensor es prácticamente una rendija. Teóricamente podría fotografiar una franja continua alrededor de la Tierra completa. No tienen tanta capacidad de almacenaje para semejante cantidad de información, por lo que se limitan a los 250 km. ¿Pero, cómo se consigue ver claramente a las personas? Aquí es donde entra el software mágico. Numerosos proveedores, tanto públicos como privados, aportan imágenes aéreas, que junto con el GPS hacen posible lo que vemos. Google tiene su propia empresa que se encarga de unir estas imágenes como si se tratara de realizar fotografías panorámicas. Después Google Earth da un paso más y fotografías todo a pie de calle con unos coches a “nivel de calle”. Aquí es donde la privacidad adquiere otro nivel más. Los viajes más famosos de la historia Goodmagazine ha recopilado en una animación flash los viajes más famosos de la historia. En total son 23 viajes, entre los que se incluyen: dijo: * La vuelta al mundo en 80 días * La expedición de Lewis y Clark * La circunavegación de Magallanes * “On de road” de Jack Kerouac * El ferrocarril transiberiano * Los viajes de Livingstone * Columbus 1942 * Viaje al centro de la Tierra * Los viajes de Marco PolO link: http://awesome.good.is/features/011/Wanderlust/WanderlustFinal.swf FUENTES FUENTE FUENTE FUENTE FUENTE FUENTE FUENTE ESO FUE TODO ESPERO QUE LES HAYE GUSTADO.
dijo:Hola gente de taringa esta es una recopilacion de articulos de ciencia que seguro que algunos les sera interesante Cuanto menos realista sea la idea de tu pareja, mejor será tu matrimonio dijo:Acostumbramos a pensar que la salud psíquica y social está asociada a un buen conocimiento de uno mismo y, también, a un buen conocimiento del otro. Ahí están esos gurús de saldo que a menudo se retiran espiritualmente a fin de conocer mejor los entresijos de su alma. O las terapias de pareja, que a menudo impulsan el abrirse al otro. Cuanto más, mejor. Pero parece ser que ello no contribuye en absoluto en una relación sana con los demás o con nosotros mismos. Al contrario. Como destaca el psicólogo Joshua Klayman, las personas adulamos nuestras preconcepciones buscando con lupa aquello que las corrobore y procurando descartar los datos que las contradigan, a veces hasta el punto de tratar de negarlos. Y eso no es malo, sino síntoma de que el cerebro funciona bien. Sólo las personas enfermas son incapaces de autoengañarse de esta manera tan efectiva. Porque el cerebro no busca la verdad, busca sobrevivir. En ese sentido, las relaciones de pareja deben fundarse en la mentira. Al menos hasta cierto punto. O las cosas pueden ser realmente complicadas. Los psicólogos Sandra Murray, John Holmes y Dale Griffin estudiaron durante un año la felicidad amorosa de más de un centenar de parejas jóvenes. La edad media del grupo era de 20 años, y el promedio de duración de las relaciones en la época del estudio, un año y medio. Lo habitual (y sano) es que uno se vea a sí mismo “mejor que el promedio” en toda una serie de aspectos de la personalidad. De igual modo, si consideramos a nuestra pareja de una forma aún más idealista, entonces la relación funciona mejor. Esta distorsión no es contraproducente, sino todo lo contrario. Las parejas que más se idolatran al principio seguían siendo una muy buena relación después de un año. En el ámbito de las relaciones afectivas, afortunadamente la realidad es un concepto muy elástico y que cambia con el tiempo. Así que, después de un año, las relaciones más duraderas acabaron siendo las que tenían una visión más idealizada y benigna de las circunstancias, por encima de la concepción alta de sí mismos y del otro. ¿Pero qué sucede cuando el tiempo sigue pasando y la química de nuestro cerebro ya no nos permite contemplar las circunstancias de una forma tan positiva? ¿Qué ocurre cuando el ideal se erosiona día a día a causa de la inclemente realidad? Entonces hay que rebajar las expectativas, y todo vuelve a quedar como habíamos soñado. Por otro lado, esta perversión de la realidad, este deslumbramiento, esta percepción exageradamente positiva del otro, tiene consecuencias que acaban siendo reales en la relación. A medida que el otro es contemplado en un altar, el otro también empieza a cambiar para mejor, como si realmente estuviera en ese altar por méritos propios. Conforme iba durando más la aventura amorosa, cada uno iba creando al compañero, que se asemejaba cada vez más a la visión idealizada; de tal manera que los sapos que ellos veían en sí mismos se convertían en princesas o príncipes encantadores, tal como sus compañeros anhelaban. O dicho de una forma un poco más drástica: las personas depresivas, propensas al ánimo lúgubre y desmotivador, de baja autoestima, precisamente destacan por tener una opinión muy realista de sí mismos y de los demás, como destacaron los psicólogos Shelley E. Taylor y Jonathan A. Brown. Para ser feliz, en parte, hay que vivir en el país de las piruletas. Descubierto: cómo las bacterias refuerzan el sistema inmunológico dijo:Desde hace mucho tiempo, se sabía que ciertos tipos de bacterias estimulan el sistema inmunológico; pero ahora, los investigadores de la Loyola University Health System, han descubierto cómo las bacterias realizan esta importante tarea. La principal autora, Katherine L. Knight, y sus colegas, publicaron su descubrimiento en un artículo destacado en la edición de 15 de junio 2010, del Journal of Immunology, disponible en línea. Knight es profesora y directora del Departamento de Microbiología e Inmunología de la Facultad de Medicina en la Universidad Loyola, Chicago. El cuerpo humano está plagado de bacterias. En cada persona, hay cerca de 10 veces más células bacterianas que células humanas. Las bacterias viven en la piel, en las vías respiratorias y en todo el tracto digestivo. Sólo en el aparato digestivo viven entre 500 y 1.000 especies de bacterias. Mientras que algunas bacterias causan infecciones, la mayoría de las especies son inofensivas o realizan funciones beneficiosas, como ayudar a la digestión. A estos bichos beneficiosos se les llama bacterias comensales. Una de las funciones más importantes de las bacterias comensales es dinamizar el sistema inmunológico. Los estudios realizados por otros investigadores hallaron que los ratones criados en ambientes estériles, libres de gérmenes, desarrollaban un sistema inmunológico deficiente. Pero hasta ahora, los científicos no conocían el mecanismo por el cual las bacterias ayudan al sistema inmunológico. El laboratorio de Knight, estudió las esporas de la bacteria en forma de bastón, llamadas Bacilo, que se encuentran en el tracto digestivo. (Una espora consiste en el ADN de una bacteria, encapsulado en una cáscara. Las bacterias forman las esporas en momentos de estrés y reaparecen cuando mejoran las condiciones de supervivencia). Los investigadores encontraron que cuando las células del sistema inmune (linfocitos B) quedan expuestas a las esporas bacterianas, las células B comenzaban su división y reproducción. También descubrieron que las moléculas de superficie de las esporas enlazan con las moléculas de superficie de las células B. Esta vinculación es lo que activa la división y multiplicación de las células B. Las células B son uno de los componentes clave del sistema inmune. Producen anticuerpos que combaten los virus y bacterias dañinas. Estos resultados indican la posibilidad de que algún día, las esporas bacterianas puedan utilizarse para tratar a las personas con sistemas inmunológicos debilitados o no desarrollados, como los recién nacidos, ancianos y pacientes sometidos a trasplantes de médula ósea. En pacientes con cáncer, las esporas bacterianas tal vez podrían estimular el sistema inmunológico para combatir tumores. No obstante, Knight advirtió que esto llevará años de investigación y ensayos clínicos, para probar tratamientos que sean seguros y efectivos. ¿Por qué los hombres encuentran tan atractivas a las rubias? dijo:Podrás negarlo y decir que a ti te van más las morenas, pero lo cierto es que el hecho de sentir atracción por las rubias (naturales o teñidas) es un fenómeno de largo historial. ¡Qué se lo pregunten a los peluqueros! El propio Darwin quiso - intuitivamente - explicar el fenómeno 10 años después de la publicación del 'Origen de las Especies', aunque fue incapaz de encontrar datos que sirvieran de respaldo a su teoría de que el cabello rubio era un rasgo provocado por la selección sexual. ¿Cómo surgieron las rubias? El debate sigue abierto, pero existe bastante consenso en que se debe a mutaciones en los genes involucrados en la producción de melanina. Las personas con bajos niveles de este pigmento cuentan con una mayor probabilidad de tener cabellos claros. Aunque pudiera parecerlo, no existe un gen único que provoque el color del cabello rubio y de los ojos azules. Y sin embargo es bastante común que estas adaptaciones se expresen al mismo tiempo, ya que los genes para ambos rasgos se encuentran muy cerca, en el mismo cromosoma. Algunos científicos aseguran que los humanos rubios y de ojos azules llevan muy poco tiempo entre nosotros. Estas adaptaciones, relativamente comunes entre los caucásicos, podrían haber surgido hace apenas 11.000 años. Se cree que estos rasgos surgieron en las tribus del norte de Europa, y que se popularizaron por acción de la selección sexual. La selección natural permite que las personas que sufren depigmentación absorban un mayor nivel de ratos ultravioletas, algo beneficioso para el organismo puesto que facilita la síntesis de la necesaria previtamina D3. Es bien sabido que en el norte de Europa las horas de luz son mucho menos abundantes que en África, así que la teoría de la Selección Natural favorecería - desde el punto de vista de la salud - a los humanos que viajaron al norte y experimentaron esta mutación. Pero volvamos al asunto de la selección sexual. Al final del paleolítico, las mujeres africanas y del sur de Europa podrían buscar frutas y vegetales y alimentarse (a ellas y a sus hijos) de este modo. De tanto en tanto los hombres cazarían presas con cuya carne equilibraban su dieta. Las mujeres del norte de Europa, en cambio, habitaban tierras cubiertas en buena parte por el hielo, por lo que eran mucho más dependientes de la carne y de los hombres que la conseguían. La carne no era fácil de conseguir. Aquellos cazadores nórdicos tenían que enfrentarse a bandadas de bisontes y mamuts, asunto peligroso y que provocaba muchas bajas. Por tanto, algunos científicos sugieren que en esos tiempos, la rivalidad sexual entre las hembras (más abundantes que los hombres) era muy grande. La teoría sostiene que cuando los noreuropeos del Paleolítico tenían que elegir, preferían a las rubias. De este modo fue la selección sexual, la que hizo que los genes de la depigmentación se extendieran rápidamente entre aquellas poblaciones. Pero el caso es que la depigmentación es un fenómeno que se da también entre tribus aborígenes no nórdicas que habitan ambientes donde no escasean los rayos del sol, por lo que en efecto parece que la teoría de que el papel de la selección sexual fue mucho más importante que el de la selección natural parece tener sentido. De hecho, una persona que nazca albina en África central tiene a causa de la superstición muchas menos probabilidades de sobrevivir hasta la edad adulta que un pariente no depigmentado. Los caballeros las prefieren rubias. La pregunta es ¿por qué muchos hombres (incluídos aquellos cazadores nórdicos del paleolítico) parecen encontrar irresistibles a las rubias de ojos azules? Algunos científicos creen que el secreto de las rubias, que suelen exhibir niveles más bajos de testosterona, radica en que poseen rasgos sexuales infantiles que suelen agradar a los hombres. Entre estos rasgos se citan por ejemplo: narices y mandíbulas más pequeñas, barbillas acabadas en punta, hombros más estrechos, piel suave y menor cantidad de vello corporal. Además, es común que también exhiben rasgos de comportamiento infantil, como mayores niveles de energía y alegría. Por si fuera poco, se cree que los hombres nórdicos preferían emparejarse con rubias para asegurarse la paternidad, con cierto grado de fiabilidad, de sus retoños. Es un hecho que los genes que expresan el cabello rubio y los ojos azules son recesivos, lo cual quiere decir que hace falta que tanto el padre como la madre cuenten con ellos para que los genes se expresen en su descendencia. Así pues, si el típico nórdico rubio y de ojos azules se apareaba con una hembra paleolítica con estos mismos rasgos y el niño nacía con ojos pardos, el disgusto estaba asegurado. Curiosamente parece que la popularidad de las rubias no ha decaído desde la última edad del hielo. ¿Qué cómo lo se? Pues... por el Playboy. Aunque parezca mentira se ha llegado a estudiar el número de mujeres rubias que ocupan las páginas centrales en esta revista, para compararlo a otra clase de revistas en las que aparecen mujeres (como las de moda). Y si, en efecto, el número de rubias que aparecieron en las páginas centrales de Playboy excede largamente el porcentaje real de mujeres con este rasgo en la población normal. ¿Dormir bien nos hace ver las cosas de otro color? dijo:Un reciente estudio estadounidense revela que, después de dormir una media de 7,7 horas, vemos los colores que nos rodean tal como son. Sin embargo, a medida que avanza el día y aumentan las horas de vigilia, nuestra percepción de los colores cambia, y percibimos el gris neutro como ligeramente verdoso o ligeramente rosado, en función de la persona y su estado de ánimo. “Pasar horas despiertos nos hace clasificar progresivamente colores neutros como si tuvieran un tono de color, mientras que dormir nos devuelve a la neutralidad en las percepciones”, explica Bhavin Sheth, investigador de la Universidad de Houston en Texas, que ha presentado sus conclusiones en la conferencia SLEEP 2010, que celebra cada año la Asociación Americana de Medicina del Sueño. ¿No llega a tomar una decisión? Coma azúcar dijo:* La falta de azúcar nos hace más impulsivos. * También provoca que las decisiones estén orientadas a un presente inmediato. * Por otro lado, lavarse las manos disipa dudas en las decisiones y elimina la necesidad de justificar una acción. Dos recientes estudios ofrecen trucos caseros que pueden ayudar a eliminar dudas sobre nuestras decisiones. Lavarse las manos e ingerir algo de azúcar puede hacer que la persona decida con mayor seguridad y probabilidad de acierto, según publican Science y Psychological Science, respectivamente. Tomar azúcar... "Cuando tenemos más azúcar en sangre (lo que supone más energía) nuestra toma de decisiones están más orientadas hacia el futuro", concluye el estudio del equipo de los científicos X. T. Wang y Robert D. Dvorak, de la universidad del Sur de Dakota. Las decisiones con vistas a un futuro no inmediato suponen un mayor desgaste por parte de nuestro cerebro, ya que se trata de algo más abstracto que el presente. Por este motivo, según este estudio, las decisiones más centradas en el presente e impulsivas pueden ser una señal de falta de azúcar en la sangre. Para investigar este supuesto, Wang y Dvorak dividieron a un grupo de voluntarios en dos. Unos tomaron una bebida con azúcar mientras que los otros consumieron una bebida con aspartamo como edulcorante. A todos se les ofreció dos posibilidades: bien recibir una cantidad de dinero inmediata, o bien esperar un tiempo y recibir una cantidad de dinero mayor. Durante el estudio se midió además los niveles de glucosa que los voluntarios presentaban. Los que tenían mayor cantidad de azúcar en sangre optaron por esperar el plazo de tiempo para recibir el dinero, mientras que los que tenían niveles menores optaron por la de recibir el dinero inmediato, aunque la cantidad fuese menor. "La falta de glucosa (relacionada con poca energía) en sangre nos fuerza a concentrarnos en el presente y nos vuelve más impulsivos", matizó Wang, en palabra recogidas por Muy Interesante. ... Y lavarse las manos Hace pocas semanas se daba a conocer un estudio curioso respecto, también, a la tomas de decisiones por parte del ser humano. Publicado en Science y elaborado por la Universidad de Michigan (EE UU), su conclusión eran tan sorprendente como rotunda: el simple gesto de lavarse las manos con jabón en el baño puede eliminar las dudas a la hora de decidir. Nos libera del sentimiento de culpabilidad en acciones inmorales del pasado y también reduce la necesidad de justificar las decisiones más recientes, explica uno de los autores de la investigación, Spike W. S. Lee. Para la investigación contaron con un grupo de estudiantes. Se les pidió que eligieran entre varios discos musicales. Paralelamente se les encuestó acerca de un jabón líquido de baño, algo que no tenía nada que ver con los discos. Los que probaron el jabón no necesitaron justificar por qué habían elegido los discos que habían elegido. No así los que se limitaron a observar el jabón líquido sin pararse a probarlo. ¿Por qué una buena memoria es mala para ti? dijo:El hallazgo de que una memoria demasiado buena hace que los animales que pastan sean menos eficientes da una idea de las fuerzas que gobiernan la evolución y la inteligencia En los últimos años, se ha dado una pequeña revolución en el estudio de los patrones de alimentación de los animales que pastan. Tras el desarrollo de nuevas formas de observación del comportamiento de estos animales, los informáticos han realizado modelos que reproducen bastante bien el comportamiento de muchos seres vivos. Lo curioso es que estos modelos están basados en paseos aleatorios. En estas simulaciones, el siguiente movimiento de un individuo es prácticamente independiente de todos sus movimientos anteriores. La memoria tiene muy poca o ninguna relevancia para estas criaturas. Estos modelos funcionan bien para procesos inanimados como el movimiento browniano y el movimiento de los billetes pero también captan el comportamiento del zoo-plancton, los depredadores marinos e incluso los monos araña. Esto es algo sorprendente ya que muchos animales han desarrollado una buena memoria que les permite realizar análisis de coste-beneficio complicados: ¿debería volver al árbol de la semana pasada o gastar mis energías buscando uno nuevo? Es fácil imaginar que una buena memoria conllevaría beneficios importantes para un animal que pasta. Pero esto no es algo simple, según Denis Boyer de la Universidad Paul Sabatier de Francia y Peter Walsh de la UNAM. Estos investigadores han creado uno de los primeros modelos computacionales que tienen en cuenta la capacidad de una criatura para recordar lugares en los que tuvo éxito encontrando comida y las veces que vuelve. Su modelo muestra que en un entorno cambiante, volver a los lugares antiguos de forma regular no es la mejor estrategia para estos animales. En vez de esto, resulta que una estrategia más útil es utilizar un componente aleatorio en el patrón de alimentación. Esto mejora el rendimiento de la alimentación en un factor mayor de 7, según Boyer y Walsh. Claramente, las criaturas de costumbres no tienen tanto éxito como sus primos oportunistas. Esto tiene sentido. Si se basan en el mismo conjunto de arbustos para su sustento, entonces tendrían problemas si estos árboles se mueren o son comidos por sus rivales. Por lo tanto, la búsqueda constante de nuevas fuentes tiene un beneficio, incluso si con ello se gastan grandes cantidades de recursos. “El animal modélico suele gastar la mitad de su tiempo viajando y volviendo a los lugares anteriores de una manera ordenada”, dijeron Boyer y Walsh. Concluyen que la memoria es útil porque permite que los animales encuentren comida sin el esfuerzo de buscarla, “pero una memoria demasiado grande evita que el animal actualice su conocimiento en ambientes muy cambiantes”, dijeron. Por lo tanto, demasiada confianza en la memoria es malo. Esto arroja luz sobre las fuerzas que probablemente gobernaron la evolución de la memoria y la inteligencia. Tómese por ejemplo la pregunta: si la capacidad de recordar es algo tan bueno, ¿por qué la evolución no nos ha dotado de memoria fotográfica? La respuesta según Boyer y Walsh es debida a que nos moriríamos de hambre cuando el supermercado local cerrase. La siguiente pregunta, por supuesto, es ¿cuáles son las mejores estrategias cognitivas para explotar una memoria imperfecta? Esperemos que podamos acordarnos de ella lo suficiente como para averiguarlo. Una nueva molécula para regenar huesos dijo:Investigadores de la Universidad Rey Juan Carlos I (URJC) de Madrid han desarrollado una nueva generación de biomatariales que simulan la picadura de un escorpión y que podrían servir para la regeneración de tejido cardiaco y óseo. Se trata de familias de compuestos con un centro activo de magnesio o zinc, que se unen a moléculas de forma similar a la picadura de uno de estos artrópodos, para formar lo que se denomina un "catalizador". Estas nuevas especies activas son capaces de generar en grandes cantidades materiales biológicamente compatibles con el cuerpo humano, como es el poliácido láctico, a través de un proceso de polimerización. Es decir, son capaces de unir la misma molécula millones de veces por minuto de forma controlada, "como si de máquinas de coser se tratasen enlazando pequeños trozos de tela de forma frenética", explicaron los investigadores en un comunicado. Entre las aplicaciones más importantes destacan las médicas, ya que estos biomateriales poliméricos pueden utilizarse en ingeniería de tejidos cardíacos (en la elaboración de 'bypass'), transporte de medicamentos (en la elaboración del material que recubre las cápsulas) y como dispositivos de fijación interna biodegradables y reabsorbibles. En este sentido, este nuevo biomaterial podría ayudan a reparar fracturas de huesos pequeños de pies y manos, y de articulaciones como muñecas y tobillos. "Estas fijaciones ortopédicas se asimilan de forma natural por el cuerpo humano, donde los polímeros se metabolizan progresivamente transfiriendo su masa al hueso roto para facilitar su regeneración", señalan desde la URJC. ¿Se puede explicar el mal con las leyes de la Termodinámica? dijo:¿Qué es la termodinámica? La termodinámica es una rama de la física que estudia los efectos de los cambios de magnitudes de los sistemas a un nivel macroscópico. Los cambios estudiados son los de temperatura, presión y volumen, aunque también estudia cambios en otras magnitudes, tales como la imanación, el potencial químico, la fuerza electromotriz y el estudio de los medios continuos en general. También podemos decir que la termodinámica nace para explicar los procesos de intercambio de masa y energía térmica entre sistemas térmicos diferentes. Para tener un mayor manejo especificaremos que calor significa "energía en tránsito" y dinámica se refiere al "movimiento", por lo que, en esencia, la termodinámica estudia la circulación de la energía y cómo la energía infunde movimiento. Históricamente, la termodinámica se desarrolló a partir de la necesidad de aumentar la eficiencia de las primeras máquinas de vapor. Si piensas que esta relación Termodinámica-mal es estrambótica, he de decirte que no es, ni mucho menos, la primera vez que se usan las leyes de la física para argumentar un comportamiento humano. (Al final os extraigo, del fantástico artículo “La termodinámica, su historia y sus implicaciones sociales. Una revisión historiográfica” de Stefan Pohl Valero, algunas ideas generales que nos demuestran hasta que punto puede ser utilizado un concepto científico para fines sociales e ideológicos.) Aunque se arriesga uno a cometer errores al interpolar las leyes de la física al comportamiento humano, voy a intentar explicar el mal con las leyes de la termodinámica. Espero no meter mucho la gamba. El mal Se ha filosofado durante toda la historia sobre el mal y el bien. El mal ha sido un concepto tratado por filósofos y religiosos durante muchos siglos. ¿Es el hombre bueno o malo por naturaleza? Parece claro que el mal y el bien son conceptos relativos que dependen de la moral y la ética de una época y sociedad determinada. Por ejemplo, la esclavitud en la Roma Antigua formaba parte de la sociedad romana, donde el esclavo constituía el escalón más bajo de la sociedad , y el propietario ejercía sobre el esclavo un poder absoluto. En ningún momento un ciudadano romano, noble y honrado, sería considerado amoral por aceptar la esclavitud como parte necesaria de la estructura social y económica. Hoy día esta “institución” no sería aceptada bajo ningún concepto. Pero actualmente también existen grandes diferencias éticas y morales entre sociedades que defienden el mismo concepto del mal y el bien. La pena de muerte, el aborto o la eutanasia pueden ser ejemplos claros. El mal en la naturaleza. El mal es un invento humano, en la naturaleza no existe el mal ni el bien. Que el león mate a las crías de otro león para procrear con la leona es pura supervivencia; que la viuda negra o el pulpo mate al macho después de procrear es supervivencia. No podemos extrapolar la moral humana a la naturaleza. Desde que la primera bacteria tuvo que comerse o utilizar a otra para sobrevivir, la vida de un ser vivo no se sostiene sin la muerte de otro. ¿Se puede explicar el mal con las leyes de la Termodinámica? ¿Puede ser que las leyes de la física sean las que empujen al ser humano a hacer el mal? Las leyes de la Termodinámica pronostican que un sistema aislado evolucionará hacia un estado de mínima energía y máxima entropía (máximo desorden). El equilibrio entre estas dos variables termodinámicas determinan si un fenómeno ocurre o no. Nosotros tendemos al desorden, pero al no estar aislados, usamos la energía del Sol para permanecer ordenados. Ahora bien, una vez que consumimos la energía necesaria para permanecer ordenado y vivos, siempre tendemos a gastar la mínima energía al realizar una actividad. Por ejemplo, para ver la televisión nos sentamos o nos tumbamos, porque nuestro estado y gasto energético es menor que viéndola de pie. Pongamos varias situaciones para intentar aclarar el asunto: 1. En un examen: Estamos delante de un examen y no hemos estudiado nada, lo hacemos mal y lo suspendemos. Hacer mal el examen requiere mucho menos gasto energético que hacerlo bien. Para hacerlo bien tengo que gastar mucha energía para pensar y memorizar durante semanas o meses. 2. Robando una televisión: Un ladrón roba una televisión. ¿Por qué lo hace? Lógicamente robar una televisión requiere mucho menos gasto energético que trabajar y ahorrar durante meses para comprársela. 3. Una mujer le es infiel a un hombre y éste mata al amante: Matando al amante resuelve el problema mucho más rápido y con menos gasto energético que aceptando la infidelidad y encontrar otra pareja. En todos estos ejemplos no sólo hace falta más energía para hacer el bien, sino que hay que emplear más tiempo en permanecer ordenados para hacer el bien. Desde que se inventó la primera herramienta se inventó la primera arma. Una azada puede servir para arar la tierra, o golpear al vecino en la cabeza y quedarse con sus tierras, duplicando así la plantación y los beneficios. Un acto que ahorra mucha energía, ya que para doblar la producción practicando el bien, el agricultor tendría que trabajar el doble, para ganar el suficiente dinero para comprar las tierras del vecino y trabajarlas. Así, el mal no es más que la tendencia del ser humano a seguir la ley física del mínimo gasto energético. “La termodinámica, su historia y sus implicaciones sociales. Una revisión historiográfica” de Stefan Pohl Valero En la segunda mitad del siglo XIX las leyes de la termodinámica tuvieron implicaciones sociales en el contexto europeo. Además de las posibilidades que parecía ofrecer el concepto de la energía para el estudio y manejo de la sociedad, el hecho de que esta misma sociedad y sus individuos se interpretaran como una máquina térmica sirvió de manera idónea para legitimar diversos ordenes sociales. En la Europa del último tercio del siglo XIX, la imagen de una compleja máquina térmica, regida por las leyes de la termodinámica, se convirtió en una de las principales metáforas que explicaban cómo el universo, la sociedad y el hombre funcionaban. Desde esta visión, las leyes de la termodinámica sirvieron para justificar toda una serie de ideologías y reformas sociales. Si entendemos el “darwinismo social” como un término que expresa las influencias e implicaciones sociales y culturales del darwinismo -la interacción entre teorías biológicas y teorías sociales - , y en el que las férreas fronteras entre lo científico y lo social parecen difuminarse, entonces podríamos igualmente hablar de la “termodinámica social.” En el libro Energy & Entrpopy. Science and Culture in Victorian Britain (1989), el lingüista Greg Myers escribió un ensayo titulado “19th Century Popularization of Thermodynamics and the Rhetoric of Social Prophecy,” en el que exploraba cómo el lenguaje de la crítica social y moral influyó en la retórica de los divulgadores de la física victoriana, y cómo el lenguaje de los físicos fue utilizado para hacer crítica social y moral. Al igual que como ocurrió con el darwinismo, tanto pensadores de derechas como de izquierdas se apropiaron de las leyes de la termodinámica para legitimar de forma científica sus posturas políticas e ideológicas Hechos fascinantes del cerebro humano dijo:El cerebro es el órgano más complejo y desconocido del cuerpo humano. Es el encargado de hacer que todo el resto del cuerpo funcione de la forma correcta. Un cuerpo, se puede mantener con vida sin cerebro, pero cuando este falla no se puede decir que esa persona esté realmente viva. Aquí listo varios hechos fascinantes sobre el cerebro humano. Algunos conocidos por la gran mayoría y otros que muchas personas desconocen. 1. El cerebro no siente dolor. Pese al hecho de que el cerebro sea el encargado de procesar las señales de dolor de otras partes del organismo, en sí mismo no puede sentir verdadero dolor. Irónicamente es el encargado de hacernos sentir el dolor del resto del cuerpo, pero no puede generarlo. 2. El cerebro tiene grandes necesidades de oxígeno. El 20% de las necesidades de oxígeno y de calorías de nuestro cuerpo provienen del cerebro, pese al hecho de que el cerebro únicamente supone (de media) un 2% de la masa corporal. 3. El 80% del cerebro es agua. Pese a ser relativamente sólido, el cerebro humano está compuesto en un 80% de agua. Esto intensifica la importancia de mantenerse totalmente hidratado por el bien de la mente. 4. El cerebro se activa por la noche. Cuando el resto del cuerpo disminuye su actividad alcanzando mínimos durante los momentos de sueño, el cerebro aumenta su actividad siendo incluso mayor que cuando estamos despiertos. Eso sí, la actividad en vigía y sueño tiene lugar en lugares distintos del cerebro. 5. El cerebro humano opera a 15 watios de potencia. Un cerebro adulto únicamente consume en un día entre 250 y 300 kcal, lo que supone una potencia de cerca de 15 watios para un cerebro de unos 1.300 – 1.400 gramos (el peso que de media tiene un cerebro humano adulto). 6. El cerebro cambia de forma durante la pubertad. Durante la adolescencia, el ser humano cambia de aspecto físico, y también cambia su forma de pensar, ya que la estructura del cerebro cambia por completo. Hasta que este cambio no ha terminado, el ser humano no es capaz de asumir los riesgos de sus acciones. 7. El cerebro puede almacenar todo. Técnicamente, el cerebro humano tiene la capacidad de almacenar todas las experiencias, todo lo que se ve, todo lo que se oye e incluso todo lo que se siente. El gran problema recae en si una vez almacenado, esa información puede ser recuperada. En la mayoría de casos esto no sucede, aunque la historia ya ha dado el caso de Jill Price, una mujer que no podía olvidar. 8. La información en el cerebro viaja a distinta velocidad. Las neuronas en el cerebro están situadas de distintas formas, y la información viaja a través de ellas a distintas velocidades. Esta es la razón por la que en algunas ocasiones se puede acceder a algo almacenado instantáneamente, mientras que en otras ocasiones toma un poco más de tiempo. 9. Un C.I. mayor equivale a más sueños. Cuanto más inteligente eres, más sueñas, pero esa no es la única curiosidad relacionada con la inteligencia y el cerebro. Un elevado cociente puede llegar a combatir las enfermedades mentales, y existen casos de personas que son literalmente más inteligentes en sueños que cuando están despiertos ¿Emborrachan más las bebidas con más azúcar? dijo:Hace dos o tres semanas llegó esta pregunta a mi casillero, pensé en contestarla inmediatamente, porque llevaba mucho tiempo sin ninguna pregunta, pero al documentarme sobre el tema, me quedé "seco". El insomnio reduce la materia gris del cerebro dijo:¿Qué es el insomnio? El insomnio es uno de los trastornos del sueño más comunes. Aunque el insomnio únicamente suele concebirse como la dificultad para iniciar el sueño, lo cierto es que la dificultad para dormir puede tomar varias formas: * dificultad para conciliar el sueño al acostarse (insomnio inicial, el más común de los tres) * despertares frecuentes durante la noche (insomnio intermedio) * despertares muy temprano por la mañana, antes de lo planeado (insomnio terminal) Esto impide la recuperación que el cuerpo necesita durante el descanso nocturno, pudiendo ocasionar somnolencia diurna, baja concentración e incapacidad para sentirse activo durante el día. ¿Qué debemos hacer para evitar el insomio? Ya se sabía que las situaciones de estrés crónico y severo –como el que produce la depresión o el trastorno de estrés postraumático- están relacionadas con volúmenes menores en las regiones del cerebro “sensibles al estrés”, como el giro cingulado o el hipocampo (área vinculada a la formación de recuerdos). Ahora, un nuevo estudio sugiere que también el insomnio crónico puede reducir el volumen de la corteza cerebral. Investigadores de diversos centros de investigación holandeses utilizaron una técnica especial llamada morfometría basada en voxels para evaluar los volúmenes cerebrales de personas con insomnio crónico, y compararon estos volúmenes con los cerebros de personas sanas sin problemas de sueños. Así, se constató que los insomnes crónicos presentaban un volumen menor de materia gris en la corteza orbitofrontal izquierda. Los científicos afirman que el insomnio tendría, por tanto, efectos nocivos para la microestructura cerebral. Los lenguajes humanos podrían adaptarse como los organismos biológicos dijo:Cuanto más se hablan más se simplifican Los lenguajes humanos podrían adaptarse como los organismos biológicos, según sugiere un estudio de la Universidad de Pensilvania en Estados Unidos que se publica en la revista 'PLoS ONE'. Los investigadores explican que una importante hipótesis que explica por qué las lenguas difieren se basa en cambios aleatorios y la deriva histórica. El inglés y el turco podrían ser diferentes debido a historias que los separan en espacio y tiempo. De hecho, esta ha sido la teoría reinante en las ciencias lingüísticas. El estudio actual ofrece una nueva hipótesis y desafía la explicación basada en la deriva. Los científicos realizaron un análisis estadístico a gran escala de más de 2.000 lenguajes de todo el mundo dirigido a evaluar si ciertos ambientes sociales se asociaban con determinadas propiedades lingüísticas. Los resultados plantean conexiones entre la evolución del lenguaje humano y los organismos biológicos. De la misma forma que organismos muy distantes convergen en sus estrategias evolutivas en determinados nichos, los lenguajes podrían adaptarse a los ambientes sociales en los que se aprenden y utilizan. Los científicos descubrieron destacables relaciones entre las propiedades demográficas de un lenguaje, como su población y la expansión global, y la complejidad gramatical de estos lenguajes. Los lenguajes con más hablantes, y los que se habían expandido por todo el mundo, tenían gramáticas más simples que los lenguajes que hablaban menos personas en regiones más limitadas. Así, los lenguajes hablados por más de 100.000 personas eran casi seis veces más propensos a tener conjugaciones verbales simples en comparación con aquellos que hablaban menos de 100.000 personas. Las poblaciones mayores tendían a tener una pronunciación y sistemas de números más simples, menos casos y géneros y en general no empleaban reglas de prefijos y sufijos complejas en sus gramáticas. Una consecuencia de todo ello es que los lenguajes con largas historias de alumnos adultos se habían vuelto más fáciles de aprender con el paso del tiempo. Aunque varios investigadores han predicho tales relaciones entre la estructura social y lingüística, el estudio actual es la primera prueba estadística a gran escala que comprueba esta idea. Para explicar cómo los ambientes sociales producen patrones gramaticales diferentes los autores proponen la 'Hipótesis del Nicho Lingüístico'. En este sentido, los lenguajes evolucionan dentro de nichos sociodemográficos determinados. Así, aunque todas las lenguas deben ser viables para su aprendizaje por los niños, la introducción de los alumnos adultos a algunos lenguajes significa que los aspecto difíciles de aprender es menos probable que pasen a las generaciones posteriores de alumnos. El resultado es que los lenguajes que hablan más personas en regiones geográficas más amplias tienden a ser morfológicamente más simples a lo largo de muchas generaciones. Descubierto el mecanismo del efecto placebo dijo:¿Qué es un placebo? Un placebo es una sustancia farmacológicamente inerte que se utiliza como control en la investigación clínica. Sirve para descartar las curaciones debidas a causas desconocidas que no serían atribuibles a la terapia que se investiga. Algunas teorías proponen que el placebo es capaz de provocar un efecto positivo a ciertos individuos enfermos si éstos creen o suponen que la misma es o puede ser efectiva (el “efecto placebo”), por causas psíquicas o psicológicas, aunque dicha opinión es objeto de controversia por un grupo de científicos y médicos. Se ha descubierto por parte de los científicos una clave para comprender el misterioso “efecto placebo”: los placebos pueden funcionar bloqueando las señales de dolor en la médula espinal antes de llegar al cerebro. El efecto placebo ha sido desde hace mucho tiempo un misterio científico: tiene lugar cuando la condición médica de un paciente responde a un tratamiento falso o con sustancias inactivas. Originalmente se pensaba que era un fenómeno psicológico relacionado con la percepción y expectativas del paciente; si la sustancia inactiva (o placebo) se ve como beneficiosa, puede ayudar a curar, pero si se ve como dañina, puede provocar efectos negativos. “Encontramos que cuando la gente experimentaba un alivio del dolor debido a la administración de placebo, también mostraba una activación neuronal reducida en la estimulación dolorosa de la médula espinal”, dijo el miembro del equipo de investigación Falk Eippert, neurocientífico del Centro Médico Universitario de Hamburgo-Eppendorf en Hamburgo, Alemania. “Esto demuestra que los factores psicológicos tales como el placebo pueden tener un profundo impacto en el procesado del dolor”. Condicionamiento y expectativas Actualmente, el efecto placebo se cree que depende principalmente de dos fenómenos – condicionamiento y expectativas. El condicionamiento es el proceso, por ejemplo, cuando vemos a un doctor varias ceces y nos ayuda a recuperarnos en cada ocasión. Finalmente estamos condicionados a mejorar simplemente por ir al doctor – no se necesita más terapia para que nos recuperemos. Las expectativas son un proceso más consciente que depende del contexto de una situación terapéutica. Por ejemplo, si tenemos la expectativa de que cierto tratamiento mejorará nuestra salud, entonces puede que mejoremos incluso aunque el tratamiento no haga nada en absoluto. Ambos mecanismos funcionan juntos y ayudan a generar beneficios terapéuticos. Los placebos son normalmente usados como ‘controles’ en experimentos que prueban nuevos tratamientos: los pacientes son seleccionados aleatoriamente para administrársele la medicina real o un placebo, y ni ellos ni la plantilla que administra el ensayo saben qué paciente ha recibido el tratamiento real. A menudo, algunos de los pacientes a los que se da sustancias inactivas también mejoran. Cuando un número sustancial de gente que toma placebo también mejora, es difícil para los investigadores determinar si un nuevo medicamento en realidad es beneficioso. Se pueden aplicar placebos a una variedad de dolencias, y cuando tienen un efecto de alivio del dolor (como en este estudio), se conocen como ‘analagesia por placebo’. En la profundidad del cerebro Aunque ha habido desde hace tiempo una comprensión de que el efecto placebo estaba enraizado en las profundidades del cerebro, los recientes avances en la tecnología de imágenes permite a los científicos escanear la actividad neuronal en la médula espinal. Esta parte del cuerpo actúa como estación de entrada al sistema nervioso central para los mensajes del dolor que proceden del cuerpo. Esto demostró que los factores psicológicos, tales como el placebo, pueden tener un profundo impacto en el procesado del dolor, afectando no sólo a áreas cognitivas en las profundidades del cerebro, sino hasta la médula espinal, donde se inhibe la actividad neuronal. A lo largo del estudio, los investigadores aplicaron calor doloroso a los brazos de 15 hombres sanos, y compararon las respuestas de su médula espinal cuando creían que habían sido tratados con una crema anestésica o un placebo. Ambas cremas, en realidad, eran inactivas. Pero los escáners IRMf (imagen de resonancia magnética funcional) mostraron que la actividad nerviosa se reducía significativamente cuando los sujetos creían que se les daba el anestésico. Endorfinas naturales Los científicos sugieren que esto puede deberse a que cuando los pacientes esperan que un tratamiento sea efectivo, el área del cerebro responsable del control del dolor se activa, liberando endorfinas naturales que viajan a través de la médula espinal para suprimir la entrada de señales dolorosas. Esto significa que los pacientes se sienten mejor sin importar que el tratamiento tenga efecto. Aunque Falk no cree que este estudio tenga ningún impacto inmediato en pacientes que sufren desórdenes del dolor, sugiere los beneficios de demostrar que es posible medir las influencias controladas en las respuestas al dolor de la médula espinal. “Esto podría ayudar en el desarrollo de nuevos tratamientos para el dolor, permitiendo a los científicos comprobar la eficacia y posible zona de acción de nuevos tratamientos”, dijo Falk. Mejor comprensión del dolor Jon Jureidini, psiquiatra de la Universidad de Adelaida en Australia, está de acuerdo en que este descubrimiento expande nuestra comprensión del dolor. “Esto es muy interesante para la comunidad científica que trabaja con el dolor. Aunque puede que muchos pacientes no se beneficien, proporciona esperanza a los pacientes terminales”, comenta. Edzard Ernst, médico en la Universidad de Exeter en el Reino Unido, e investigador especialista de la validez de remedios alternativos está intrigado por los hallazgos. “Este estudio proporciona un novedoso mecanismo para explicar cómo un placebo podría disminuir la sensación de dolor a nivel del sistema nervioso. Por supuesto, los hallazgos requieren de una replicación independiente, pero ciertamente dan que pensar y son emocionantes”, comenta. FUENTES Fuente Fuente Fuente Fuente ESO FUE TODO ESPERO QUE LES HAYE GUSTADO

Pez Pescador: El macho que se transforma en un simple pene de la hembra Las diferencias que pueden haber entre machos y hembras en la naturaleza pueden ser muy grandes, pero el premio mayor se lo lleva el Pez pescador un orden de vertebrados, Ceratioideos, que comprende unas once familias y cien especies. Pero hablaremos en especial del Demonio marino de triple verruga, nombre científico Cryptopsaras couesii, un pez en el que el macho mide unos 3 centímetros de largo, mientras que la hembra… mide 30 centímetros, un décimo del tamaño de las hembras. Los peces pescadores suelen vivir entre los 1000 y 3000 metros de profundidad, donde hay poca alimentación y no se suelen ver muchos compañeros, ni muy seguido. Se les llama peces pescadores, justamente porque a eso se dedican, a pescar su alimento, no lo cazan. Las hembras tienen su primera espina de la aleta dorsal desplazada hacia adelante sobre su enorme cabeza. En el extremo de la espina hay un señuelo, que les sirve, literalmente, para pescar a sus presas. Ese señuelo es una luz, justamente algo que escasea a tanta profundidad. Tienen unas glándulas luminiscentes que hacen resplandecer ese señuelo, una trampa mortal para las presas, y tal vez un foco de atracción para los machos. ¿Y para qué quiere atraer así a los machos? Uno está acostumbrado a que en la naturaleza los machos suelan ser los más bellos y quienes tienen que atraer y conquistar a las hembras, pero como vimos en en otro artículo esa idea que tenemos es porque la mayoría de nosotros conoce muy poco de la naturaleza, ya que son más los machos diminutos. Macho del pez pescador adherido a la hembra.En el caso de la mayoría de las especies de los peces pescadores, los machos pasan su primera etapa nadando libres, tan pequeños como un décimo del tamaño de la hembra. Pero cuando son atraídos por una de ellas, ya en estado adulto, se convierten en un mero apéndice de la hembra. Con respecto al Demonio marino de triple verruga (Cryptopsaras couesii) en especial, el macho deja de funcionar como organismo independiente, su boca se sella a la piel de la hembra, y hasta sus sistemas vasculares se unen. Ya no se alimenta por si mismo, sino que depende de la sangre de la hembra para su nutrición. El macho se ha convertido en una especie de pene incorporado de la hembra, ya que a cambio del alimento ofrecen su esperma para fertilizar los óvulos de la hembra. Así el macho pierde algunos órganos que ya no necesita, como los ojos, pero sigue bombeando la sangre que la hembra le envía con su propio corazón, y respira con sus propias agallas. Eso sí, ahora no es más que un apéndice de tres centímetros que sobresale de la piel de una hembra de 30 centímetros de largo. Lo extraño es que no son monógamos, no es extraño ver a una hembra con varios machos adosados a su piel. FUENTE
dijo:Hola taringueros en este post les dejo 5 mitos El mundo es cada vez más violento % de muertos en guerra, tal y como aparece en “La tabla rasa”, de Steven Pinker. Vivimos en un mundo cada vez menos violento en el que, sin embargo, la percepción de peligro es mayor que nunca. Esta disonancia cognitiva hunde sus raíces en el creciente poder de la industria del miedo, tal y como analizó Barry Glassner en su clásico “The culture of fear” y en el efecto amplificador de los medios: hoy nos enteramos al minuto de las pocas docenas de muertos que se producen en las revueltas de Bangkok pero nadie se enteró en su día de los millones que murieron, por ejemplo, durante la mal llamada Revolución Cultural china. Las sociedades occidentales viven atenazadas por miedos imaginarios o bien desproporcionados a su peligro real. Mucha gente contestará que el principal problema de su barrio o de su ciudad es la inseguridad pero si le preguntas si ha sido víctima directa de algún acto violento o delictivo te dirá que no: la inseguridad es algo que flota en el ambiente. Es significativo que los españoles, que tiene una de las tasas de criminalidad más bajas de la OCDE tengamos una percepción del peligro al delito similar a México, según muestra el último informe de esta organización (sólo Japón nos gana en paranoia). La mejor receta contra la percepción subjetiva son los datos objetivos, así que vamos con unos cuantos mitos y los datos que los refutan: Los pueblos tradicionales son menos violentos que los modernos -Durante el convulso siglo XX, con sus dos guerras mundiales, aproximadamente el 1% de los varones adultos murieron por la guerra, una tasa ínfima respecto a los porcentajes de grupos amazónicos como los jíbaros (60%) o yanomami (37%), como documentó el arqueólogo Lawrence Keeley (citado en “La tabla rasa”). Curiosamente, desde el punto de vista occidental esos pueblos viven en una pacífica armonía con la Naturaleza, según retrata “Avatar”, cuando en realidad la vida de sus miembros suele ser corta, miserable y finaliza de una forma brutal. Cualquier tiempo pasado fue más pacífico -También tendemos a idealizar el pasado, pero casi cualquier período de la Historia es varios órdenes de magnitud más violento que nuestro presente. La tasa de homicidios en la Edad Media en Inglaterra era entre 10 y 20 veces más alta que en el siglo XX. En Amsterdam, este índice pasó de 47 homicidios por cada 100.000 personas en el siglo XV a 1,5 en el XIX, según los hallazgos de la Sociedad Americana de Criminología. En comparación, la tasa de homicidios mundial es del 10 por 100.000 individuos, aunque llega a multiplicarse por 5 en países como Colombia o Sudáfrica. Las ciudades son más violentas que el campo -Ese mismo estudio derribaba otro mito muy asentado: las ciudades son más violentas que el campo. Para sorpresa de los investigadores, las bucólicas aldeas medievales eran en realidad el marco de una lucha hobbesiana por la supervivencia. Todos los habitantes –incluidas las mujeres- portaban un cuchillo y la manera habitual de resolver un conflicto era mediante la violencia. -Pero aunque la criminalidad era altísima en la Edad Media, en realidad era mucho más baja que tiempos ancestrales. Según estudiaron los sociólogos Daly y Wilson, en las sociedades preestatales entre el 10 y el 60% de los hombres mueren a manos de otros hombres. De hecho, escriben, “durante la Edad Media las personas aceptaron unas autoridades centralizadas para librarse del peso de tener que tomar represalias contra quienes les dañaban”. Toda una lección para los defensores del anarquismo. Las guerras se cobran cada vez más víctimas -El porcentaje de víctimas mortales en las guerras no deja de reducirse, lo que no deja de ser contraintuitivo, teniendo en cuenta la indudable mejora de la tecnología para matar. El historiador Adamson calculó que en torno al 90% de los soldados que participaban en las guerras griegas fallecían, un porcentaje que se redujo al 20% en la II Guerra Mundial y al 16% en la Guera de Corea. Con todo esto no pretendo concluir que el mundo es hoy un jardín de rosas en el que la violencia es algo excepcional. En muchas partes del mundo vivir es una profesión peligrosa, las guerras convencionales han dejado paso a otro tipo de violencia, como la que enfrenta hoy al narco con el Estado mexicano; la mayoría de las víctimas en conflictos violentos son actualmente civiles y, por último, existe una indudable violencia simbólica, pero al contrario que la violencia real ésa no mata. Y eso no deja de ser una ventaja. Adicción a internet No es la herramienta, es lo que haces con ella, estúpido Adicción a los libros, adicción al radio, adicción a la televisión, adicción a los videojuegos, adicción a los teléfonos móviles, adicción al internet. A lo largo de los años, las personas que nacieron antes de la popularización del medio de moda tratan de explicar de la peor manera posible los comportamientos de consumo de la generación que les sucede. Actualmente esto sucede con la supuesta adicción al internet. Se supone que quienes estamos “todo el día online” somos unos adictos, personas que no podemos “desconectarnos” y que por lo tanto tenemos un problema. Un problema que es solucionable. Decir que somos adictos al internet es como decir que somos adictos al papel. O decir que quienes hacen muchas anotaciones son adictos a los cuadernos. Es imposible ser adictos a los cuadernos, a los papeles o al internet. Es neutral. Es posible y lógico volvernos adictos a una actividad, pero es ridículo creer que nos podemos volver adictos a un medio o una herramienta. El argumento de la adicción se vuelve aún más ridículo cuando estamos pasando a un sistema de conexión perpetua. Cada día más teléfonos están siempre conectados, en la actualidad tenemos tres ofertas populares que simplemente no funcionan bien si no están online (Android, BlackBerry, iPhone); el ADSL o 3G para ordenadores son lo normal. Por lo tanto decir que estás adicto al internet sería equivalente a decir que somos adictos al TDT. Pero imaginemos por un momento que el argumento es válido. Lo curioso es que los métodos de medición de esa supuesta adicción no logran sostenerse por si mismos; un estudio hecho por Dowling & Quirk en 2008 analizó el método usado por casi todos los examinadores del “fenómeno”. El Cuestionario de Diagnóstico de Young (desarrollado por el originador del “desorden”, Kimberly Young) no logra determinar diferencias estadísticas entre supuestos “adictos” y “normales”. Con apenas ocho preguntas es poco probable que se pueda determinar entre un uso “normal” y “problemático”. Por lo tanto los investigadores han estado usando formas extremadamente inexactas para determinar una disfunción que ni siquiera existe. ¿Hay adicciones a actividades que se desarrollan online? no lo dudaría; si las adicciones son formas de suprimir el dolor o la privación de ciertas cosas, suena lógico que se encuentran actividades online que logren parar ciertas dolencias y/o carencias. El problema es que la “adicción a internet” llama mucho la atención, es un tema muy recurrido en medios tradicionales porque causa morbo, porque es tratado de una forma sumamente amarillista que seguramente genera audiencias y de paso sataniza a un medio que les está quitando terreno. Es fácil ponerle una etiqueta a personas para explicar un fenómeno que no se entiende. Pero son problemas que se atribuyen sin ofrecer prueba o explicación alguna. Lo más curioso es que, quienes suelen achacarnos la supuesta adicción, son señores o señoras que terminan de escribir su artículo (o editar el video) y se levantan del escritorio para salir a fumar como desesperados o terminan en un bar borrachos porque odian su trabajo. Aja, sí, pero los adictos somos nosotros. El mundo está cada vez peor (y esto no hay quien lo arregle) El pesimismo tiene un prestigio inusitado, especialmente entre la progresía y la gente comprometida. Habría que estar ciego para no darse cuenta de que en el mundo hay hambre, violencia y enfermedades por doquier. Desdichadamente esto siempre ha sido así y así seguirá siendo. La buena noticia es que cada vez hay más gente que disfruta de una vida mejor, y no me refiero a los países privilegiados sino a todo el mundo: hay menos hambre, menos violencia y menos enfermedades en casi todos los lugares del mundo. Si dices esto en público te arriesgas a ser tomado por un bobalicón optimista, porque desafía la cosmovisión más extendida de que cualquier tiempo pasado fue mejor y todo, indefectiblemente, va hacia el desastre. Esa percepción del mundo suele estar basada en percepciones subjetivas (inexactas, como es bien sabido) o, aún peor, en la crónica periodística, condicionada por la máxima “bad news is good news” e incapaz de narrar progresiones, especialmente cuando éstas son positivas y no tienen grandes hitos noticiables que narrar (por ejemplo, el retroceso del desierto en la zona del sub Sáhel gracias a la introducción de nuevas técnicas de cultivo no es noticiable, pero sí lo es la merma del mar de Aral, con sus barcos varados en mitad de la nada). Frente a la sesgada percepción individual y periodística sólo nos queda la big picture de la estadística, por imperfecta que ésta sea, mucho más cercana a la realidad. Los espectadores españoles tuvieron ocasión el pasado 30 de mayo de ver en acción a Hans Rosling, un mago de la visualización de datos, al que muchos ya conocíamos gracias a sus espectaculares charlas en TED. Rosling fue el invitado de Eduardo Punset en Redes, en un programa llamado igual que esta serie de artículos que escribo para Cooking Ideas: “Desmontando mitos sobre el mundo”. El programa diseñado por el equipo del profesor Rosling para la visualización de datos, Gapminder, permite observar de una forma muy intuitiva la evolución de países y regiones a lo largo de series temporales relativamente extensas. La sorprendente conclusión suele ser que los países que consideramos “del Tercer Mundo” se acercan a los estándares de vida (esperanza de vida, mortalidad infantil, ingestión de calorías, etc.) que tenemos en el mundo desarrollado a una velocidad mucho más grande de la que nos imaginamos. De hecho, ya no existe tal distinción entre los mundos primero, segundo y tercero que nos enseñaron en los 70-80, con la triste excepción de buena parte del África subsahariana, que no hace más que divergir de la evolución generalizada. La visión del profesor sueco es compartida por el zoólogo Matt Ridley, quien en su libro “The Rational Optimist: How Prosperity Evolves” compara el intercambio económico, la esencia del capitalismo, con el intercambio sexual, y concluye que dijo: “(…) la gran mayoría de la gente dispone de mejor alimentación, hogar, entretenimiento y protección de las enfermedades y tiene la oportunidad de vivir más que sus antepasados. La capacidad de casi todo lo que una persona puede desear ha crecido rápidamente en los últimos 200 años y erráticamente en los 10.000 anteriores: años de vida, agua limpia, aire puro, horas de intimidad, medios de locomoción más rápidos que correr y medios de comunicación más potentes que la voz”. Sumergidos como estamos en un zeitgeist preapocalíptico estos asertos entran en la categoría de antema. Y es que el problema con hacer este tipo de afirmación en público es que, con la que está cayendo, te pueden acusar de retrógrado o de vendido al capital. Pero si observamos los datos desapasionadamente no queda otra conclusión que no sea que vamos a mejor, aunque sea con altibajos y algún doloroso ajuste (efectivamente: puede que los europeos vayamos a peor, pero eso que nos vamos a ahorrar en remordimientos en un par de generaciones). Pero veamos las cosas con perspectiva: la crisis actual puede dejarnos sin vacaciones (y sin coche y sin casa a algunos) pero no es previsible que vaya a desencadenar una hambruna como la que asoló Irlanda hace sólo 150 años y que aniquiló a una cuarta par de la población. Una descarga equivale a una venta menos Una de las frases favoritas de algunos de los directivos más longevos de discográficas, estudios de cine, productoras de televisión y sociedades de gestión colectiva que empiezan con S y terminan con E: Una descarga equivale a una venta menos ¿Lo es? De buenas a primeras “suena lógico”, una persona que entra a internet, abre su programa favorito de P2P y se descarga el último disco de su banda/artista preferida en menos de 20 minutos, está disfrutando de la música y cualquier necesidad de ir por el disco se desvanece. Pero que suene lógico no significa que lo sea, tampoco significa es que es una realidad. La mejor forma de entender por qué una descarga no equivale a una venta menos es mirar al pasado y analizar la forma en que hemos interactuado con la cultura a lo largo de los años: En la década de los setentas y de los ochentas era la cosa más normal del mundo el grabar cintas (cassettes) con música de discos de vinil y luego CDs de nuestros amigos, también era normal intercambiar estas cintas e inclusive los mismos discos. ¿Por qué voy a comprar el CD si ya tengo la grabación en un cassette, gratis? No se diga con la música que grabábamos de la radio. También sucede lo mismo con los VHS y las películas que pasan en TV, era práctica habitual el grabarlas y después verlas o prestárselas a los amigos/familiares. Una venta menos, ¿no? No necesariamente. La industria usa las “ventajas del formato físico” como excusa/motivo para que los usuarios sí compraban la música aunque ya la tuvieran grabada, es decir: * Más calidad: un CD tiene mejor calidad que un cassette o un VHS grabado de la TV tiene menos calidad que un original. * Comodidad: un CD es un formato más cómodo que el cassette. ¿Pero realmente nos importaba la calidad? Después de todo, la gran mayoría de las personas ya escuchan música en el radio y ya ven películas en la TV donde la calidad no era precisamente la mejor. La verdad es que a la gran mayoría de las personas la calidad le importa poco o nada. La gran mayoría de las personas escuchaban música de mala calidad por medio de una grabación hecha en un equipo de sonido barato. De la misma forma en que hoy no nos importa ver videos en YouTube con una compresión de mierda, durante años escuchamos MP3 mal encodeados y hoy es normal que un sector de la población (descritos como “jóvenes y adolescentes”) vean videos de música en una pantalla de 2 x 2 pulgadas de su teléfono móvil (ojo, no dije “smartphone”). Aún así, en los setentas y los ochentas, con ese tráfico de cultura (música, video, películas) en formatos análogos, la venta de música seguía estando por los cielos. Los LPs y después los CDs se vendieron como pan caliente. La industria era feliz, MTV era feliz y los padres no eran felices porque sus hijos gastaban 14,99 dólares por cada disco que el niño quería. ¿Por qué? Porque tenemos más contacto con la cultura que nos rodea. Al escuchar más música, al ver más videos, al ver más películas nuestro “apetito cultural” aunmenta, se desarrolla y nos pide más. En los setentas y los ochentas la única forma de conseguir más era buscando el disco en una tienda de música o comprando la película en el Blockbuster. Los tiempos avanzan, llega internet, aterriza Napster y la industria (junto a Lars Ulrich) se vuelve loca, se jala de los pelos, se da contra las paredes y gritan ¡¡escándalo!! — ¿Cuál es el miedo? Que “de repente” todos los clientes potenciales no necesitan ir a la casa del amigo para grabar la música en calidad cutre, simplemente hacen un clic y la canción está en el disco duro. ¿Pero eso hace una gran diferencia? Sí y no. Aunque ahora el internet tenga potencialmente todo el catálogo musical, de series de TV y películas que se han producido a lo largo de nuestra historia, nosotros seguimos teniendo el mismo tiempo para escucharla y/o consumirla, eso no ha cambiado. Lo que sí ha cambiado (para pesar de la industria audiovisual) es esa necesidad cultural y la forma en que pretenden encontrarla: una tienda física ya no es suficiente porque el catálogo de música/películas está restringido a lo que la tienda tenga físicamente, a lo que las discográficas o los estudios emvíen/impriman. Hoy las personas buscan nichos, buscan cosas sumamente específicas y esperan encontrarlas. Los formatos físicos lamentablemente no pueden cubrir esa necesidad. Aún así, las discográficas y los estudios de grabación insisten en que tenemos que ir a comprar el Blu-Ray o el CD. También está el tema de la disponibilidad (es decir: si aún les quedan discos o no). ¿Qué pasaba en los ochentas cuando el último disco de Michael Jackson se agotaba? Había que hacer filas en otros lugares o regresar a casa porque no había de otra. ¿Qué pasa hoy si el último de Miley Cirus se agota? Lo bajas de internet. Si la industria de adapta a los tiempos, está comprobado que se puede dar un éxito comercial, lo vivimos hoy en día. Estados Unidos, uno de los países donde más descargas, en general, hay, es también el país con la tienda de música más exitosa de la historia, que no es Walmart, Virgin o Tower Records, es el iTunes Music Store que ha vendido más de 10 mil millones de canciones (dato de Febrero 2010). Diez mil millones de canciones. De verdad. Hoy vivimos en una época donde hay una disponibilidad de cultura impresionante, omnipresente, y si le das a las personas las herramientas correctas, responderán de forma adecuada. iTunes es la forma más sencilla de comprar música hoy en día, por lo tanto tiene el éxito comercial que tiene y es una de las pruebas que descargar una canción no equivale a una venta menos. Algunas personas de la Universidad Noruega BI estaban bastante curiosos con respecto a las personas que descargan música y cómo interactuan con la industria comercial, e hicieron un estudio conde encontraron que quienes tienen la costumbre de bajar música son quienes más compran música. Diez veces más. El estudio no se apoyó en la simple palabra de los entrevistados, quienes tuvieron que entregar los recibos de compra para comprobar que es cierto. Una descarga equivale a 10 ventas. El problema de la industria audiovisual no es el internet. Esa es su principal ventaja, el problema es que aún no se han dado cuenta que sus consumidores no están dispuestos a seguir comprando formatos físicos, a ir a tiendas o a dedicar tanto tiempo en adquirir cultura a precios tan altos. Sólo utilizamos el 10% de nuestro cerebro El cerebro humano es un voraz fagocitador de energía: consume el 14% del total del cuerpo aunque su volumen sólo representa el 3% del cuerpo. Aunque ese 3% parezca poco los humanos somos bastante cabezones, como han aprendido con dolor las madres en el parto. Y la macrocefalia de los humanos podría ser aún mayor si no fuera porque la evolución ideó un ingenioso truco para multiplicar la superficie de la corteza cerebral: plegarse una y otra vez en infinidad de circunvoluciones, resultando su característica forma de nuez. ¿Tiene sentido evolutivo todo este esfuerzo para que luego sólo utilicemos un 10% de nuestro cerebro? No, como ha demostrado desde hace tiempo gente que sí parece utilizar el 100% de su correspondiente encéfalo. La afirmación no sería más que uno de tantos mitos que circulan por ahí si no fuera porque su mención encubre -en ocasiones- intenciones taimadas. El mito del cerebro infrautilizado se usa asiduamente también en círculos “espirituales” como una forma de explicar dónde se ubican ciertos poderes psíquicos (telequinesia, telepatía, teletransportación, entre otros) que, potencialmente, todos deberíamos poder desarrollar. También puso su granito de arena en difundir el bulo el inefable Dale Carnegie, pionero de la autoayuda y autor de “Cómo ganar amigos e influir sobre las personas”. El folleto que ilustra este artículo lo cogí esta mañana del parabrisas de un coche aparcado en una rúe madrileña. Lo distribuye Dianética o, lo que es lo mismo, la Iglesia de la Cienciología, secta que tiene en Madrid una fabulosa sede pagada, dicen, por el mismísimo Tom Cruise. La promesa de los cienciólogos (o dianéticos) es que gracias a las técnicas diseñadas por Ronald Hubbard, a la sazón fundador de la secta, acabaremos utilizando parte o todo del 90% restante. Demostrar que la afirmación de que sólo utilizamos el 10% de nuestro cerebro es falsa o imprecisa no desacredita la obra de Hubbard ni a la Cienciología como ciencia (que se desacredita a sí misma de sobras) pero es un buen principio para desarmar su edificio ideológico. Vamos a ello: dijo: El cerebro actúa como una máquina reductora de la realidad. Si reaccionáramos a toda la información que captan nuestros sentidos a cada instante nuestro cerebro colapsaría y se volvería inoperante.Por ese mismo motivo nunca estamos utilizando el 100% de nuestro cerebro, sino el porcentaje necesario para cumplir la tarea que realicemos en ese momento. El cerebro tiene una increíble plasticidad: un catador de perfumes desarrolla extraordinariamente el área del cerebro correspondiente al olfato.El hecho de que las neuronas estén ubicadas exclusivamente en la corteza cerebral también podría llevarnos a la conclusión errónea de que el resto de la masa encefálica no “piensa”, sólo hace bulto. ¿Qué contiene ese 90% del cerebro que no utilizamos, según la Dianética? dijo:“(…) una parte perjudicial de la mente, previamente desconocida, que contiene grabadas las experiencias pasadas de pérdida, dolor e inconsciencia en la forma de imágenes mentales. Estos incidentes de trauma espiritual se graban junto con otras experiencias de la vida del individuo en un orden secuencial que los Cienciólogos llaman la línea temporal. Los dolorosos incidentes grabados en esta línea temporal existen bajo el nivel consciente de la persona y se acumulan colectivamente para formar lo que se denomina la mente reactiva”. El modelo de negocio de la Cienciología gira en torno a donaciones por “auditación” y “formación”, como explican en su página web, y por la venta de libros y vídeos a unos precios desmesurados, como no explican. La Cienciología sería algo así como un Círculo de Lectores de lujo y con opción a vida eterna. Puestos a escuchar teorías excéntricas sobre el cerebro me quedo con esta otra: las circunvalaciones del cerebro se producen cada vez que te aprendes el nombre de un famoso (gentileza de Fake Science). Gracias por pasar